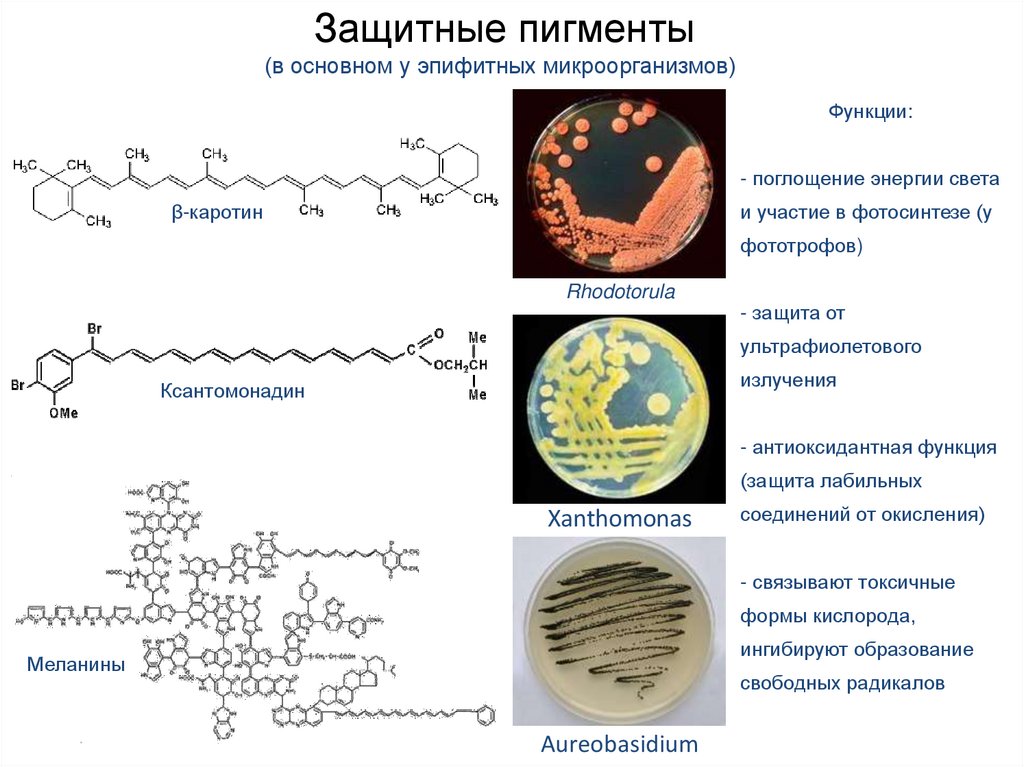

КАК ФОРМИРУЕТСЯ ПРИРОДНЫЙ ЦВЕТ ВОЛОС
Корни волос являются живой материей, поэтому нуждаются в деликатном обращении. Прежде чем приступать к любой процедуре, влекущей за собой изменение цвета волос, необходимо понимать, как и почему происходят эти изменения.
Чем выше уровень ваших знаний, тем больше клиент будет вам доверять и прислушиваться к вашим советам.
Природный пигмент меланин
Природный цвет волос формируется маленькими гранулами пигмента меланина, которые находятся в волокнистом слое волосяного кортекса. Когда свет попадает на гладкие чешуйки кутикулы, некоторые волны светового спектра отражаются полностью. Некоторые лучи проникают сквозь прозрачные чешуйки кутикулы и отражаются от более глубоких слоев. Цвет, воспринимаемый нами, зависит от того, какие именно волны светового спектра отражаются от структуры волоса. Тип, количество и пропорции смешивания двух природных пигментов внутри волоса определяют его цвет.
За выработку меланина внутри волосяной луковицы отвечают клетки меланоциты. Катализатор тирозин, находящийся в структуре клеток-меланоцитов, отвечает за запуск химической реакции, в результате которой начинается производство пигмента. Существует два типа пигмента: эумеланин – серо-коричневый пигмент, и феомеланин – теплый, красно-желтый пигмент.
Комбинация эумеланина и феомеланина определяет природный цвет волос. Глубину цвета задает концентрация пигментов.
Глубина и оттенок
Понятия «глубина цвета» и «оттенок» помогают определять и описывать цветовые типы. Глубина цвета определяется количеством пигмента, находящемся в волосе: чем больше пигмента, тем волосы темнее, и наоборот – чем меньше пигмента, тем они светлее.
Пигмент эумеланин в этом аспекте оказывает больше влияния из-за своего темного цвета. Глубину тона можно разделить на десять уровней, от черного до блондина, однако в пределах каждой глубины тона имеется множество нюансов и направлений цвета.![]()
Феомеланин, главным образом, отвечает за оттенок волос. В процессе окрашивания в более светлые тона, волосы проявляют свою природную комбинацию пигментов, так называемый «скрытый оттенок» (подтон). Очень важно определить его заранее, при анализе природного цвета волос во время консультации, поскольку природный подтон влияет на конечный результат окрашивания. В некоторых случаях потребуется его дополнительно осветлить или нейтрализовать с помощью комплементарного оттенка, воспользовавшись цветовым кругом, для достижения оптимального цветового результата.
Уровень глубины тона определяется в соответствии с общепринятыми международными стандартами:
- Уровни 1-4: основной подтон – красный
- Уровни 4-5: основной подтон – красно-оранжевый
- Уровни 5-6: основной подтон – оранжевый
- Уровни 7-8: основной подтон – оранжево-жёлтый
- Уровни 9-10: основной подтон – жёлтый
Пигменты, обусловливающие окраску шерсти. Кожа и шерстный покров собаки. Научный, ветеринарный и косметологический аспекты
Пигменты, обусловливающие окраску шерсти
Все многообразие окрасок млекопитающих обусловлено наличием или отсутствием пигментов — меланинов. Пигменты выполняют в организме многообразные функции. Они играют важную роль в клеточном метаболизме, зрительной рецепции, обусловливают адаптацию кожных покровов к внешней среде, защищая организм от действия ультрафиолетового излучения. Меланины присутствуют не только в покровах, но и в мозговых оболочках, а также в меланоцитах опухолей. Поскольку пигментные клетки закладываются в нервном валике на ранних стадиях эмбриогенеза, то часто нарушения пигментации сопутствуют тяжелым поражениям нервной системы и органов чувств. Такое наблюдается, например, у белых голубоглазых кошек и собак, страдающих врожденной глухотой.
Окрас шерстного покрова зависит от типа пигмента, формы пигментных гранул и распределения их по волосу.
Меланины представлены двумя формами: эумеланином и феомеланином, которые существуют в виде пигментных зерен, или меланосом разнообразной формы. Восприятие цвета зависит от преломления света, проходящего через них или отражающегося от них. Химический состав эумеланинов и феомеланинов одинаков: это полимеры индол-5,6-хинона.
Эумеланин — сложный азотсодержащий гетерополимер, и он присутствует в коже и волосах. Он нерастворим в органических растворителях и устойчив к химической обработке.
Феомеланин образуется только в волосяных фолликулах и не встречается в коже. Он представляет собой серусодержащее соединение, растворимое в щелочах.
Оба вида пигмента образуются в организме из аминокислот с ароматическими ядрами — фенилаланина и тирозина. Для образования меланина в шерсти млекопитающих требуется не менее восьми ферментов. Так, первый переход из фенилаланина в тирозин катализируется ферментом 1,2-фенилаланин-4-гидроксилаза, второй — из тирозина в диоксифенилаланин — ферментом тирозиназа.
Эумеланин имеет две модификации: черный — собственно эумеланин — и коричневый (возможно, и не один), являющийся мутантной формой черного. Гранулы эумеланина имеют несколько вытянутую эллипсоидальную или сферическую форму и могут достаточно сильно варьировать по размерам. Они придают волосу, в особенности его чешуйчатому слою, высокую механическую прочность и упругость.
По биофизическим характеристикам выделяют три модификации феомеланина: желтой, оранжевой и красной окраски (Алиев, Рачковский, 1986, 1992). Гранулы феомеланина гораздо мельче эумеланиновых и имеют шарообразную форму. Структура клеток волос, содержащих только феомеланин, характеризуется значительно меньшей прочностью, чем клеток, содержащих эумеланин (Коновалов, 1983). Волосы, окрашенные феомеланином, менее устойчивы к механическим воздействиям.
Оба вида меланинов присутствуют практически всегда одновременно, причем важно отметить, что одновременно могут присутствовать один тип эумеланина и один тип феомеланина. Они могут по-разному распределяться по волосу. Так, у животных окраса «агути», или зонарно-серого, в одной и той же волосяной луковице образуются и феомеланин, и эумеланин, которые располагаются по длине волоса в определенной последовательности. У собак черного или коричневого окраса феомеланин присутствует в волосе, наряду с эумеланином, но «замаскирован» последним, поэтому волосы имеют черный или коричневый цвет. На биосинтез той или иной формы меланина влияют условия клеточной среды.
Как стареют волосы
Как стареют волосы
Волосы в их натуральный цвет окрашивают пигменты, которые называются меланинами. Различают два типа меланинов, окрашивающих кожу и волосы в их природный цвет:
- Эумеланин — черный/коричневый;
- Феомеланин — красный/желтый.
Эумеланин — это пигмент, отвечающий за окрашивание кожи и волос в темный цвет. Известно, что этот пигмент поглощает УФ-радиацию, в то время как другой тип меланина, феомеланин, такими свойствами не обладает. Вот почему людям со светлой кожей и светлыми от природы волосами нужно беречься от солнца, особенно это касается рыжеволосых. Обычно у людей вырабатываются оба пигмента, в большей или в меньшей степени; однако у рыжеволосых имеется генетическая мутация рецептора меланокортина, из-за чего эумеланин не вырабатывается. Цвет кожи и цвет волос в общем случае не зависят друг от друга; так, в Ирландии или в Шотландии не редкость люди с черными волосами и синими глазами, а их кожа при этом очень бледная и без веснушек.
Меланины вырабатываются в специальных клетках — меланоцитах.
Затем гранулы меланина перемещаются в кератиноциты растущего волоса, распределяясь по всей его длине. В отличие от меланинов кожи, которые
вырабатываются в постоянном режиме, и этот процесс может быть простимулирован, например, УФ-излучением, меланины волосяного фолликула вырабатываются только в процессе роста волоса, то есть — в фазе
анагена. Это означает, что производство меланинов, пигментирующих волос, имеет циклическую природу. Каждый цикл конкретного волоса продолжается столько, сколько продолжается его анаген (фаза роста).
Когда волос переходит в фазу катагена, производство меланина прекращается, но производство кератиноцитов еще идет. Вот почему проксимальный конец волоса, выпавшего в результате нормального цикла,
не окрашен.
Во время фазы телогена меланины не производятся. В фазе телогена находится обычно менее 30% всех волосяных фолликулов. После того, как фолликул «просыпается» и начинает очередную фазу роста, его меланоцитовый аппарат также возобновляет свою работу. Биохимия происходящих там процессов достаточно сложна и не до конца понятна. Например, остается неясным, заменяются ли меланоциты на новые на протяжении последовательных фолликулярных циклов, и если да, то в каком количестве.
Цвет волос меняется на протяжении жизни человека, особенно у человека европейского происхождения. Наиболее светлые волосы у нас в раннем детстве, затем они постепенно становятся все темнее и темнее, пока, наконец, не начнет появляться седина. Волосы темнеют под влиянием гормонов, включая эстрогены и тестостерон. После тридцати лет, в среднем, человек начинает терять меланоциты, со скоростью примерно 10%-20% каждые 10 лет. Волосы седеют, кожа бледнеет, глаза выцветают. Печально, но факт.
Возможно, некоторая ирония судьбы заключается в том, что волос, лишенный пигмента из-за гибели меланоцитов, может расти даже быстрее, чем тот же волос, но пигментированный.
А еще некоторые исследования
показывают, что в седых волосах повышено содержание пероксида водорода, но неизвестно, является ли это одной из причин поседения или все же его следствием. Кроме того, в седом волосе кератиноциты
становятся несколько другими, чем в пигментированном волосе, и это обстоятельство хорошо известно парикмахерам. Седой волос труднее окрасить, он более грубый на ощупь и труднее укладывается.
Стандартно, европейцы в среднем начинают седеть около 35 лет, азиаты — ближе к 40 годам, африканцы — около 45 лет, т.е., позже всех. К 50 годам примерно 50% людей имеют 50% седых волос. Однако то, когда именно начнет седеть конкретный человек, определяется его наследственностью.
Седина, однако, может быть обратимой. Известны случаи возвращения пигментации волос после определенного вида терапий (в качестве побочного эффекта, разумеется). Возможно, это связано с тем, что волосяной фолликул содержит в себе стволовые клетки, которые при соответствующей стимуляции могут дифференцироваться в специализированные клетки. Почему бы и не в меланоциты?
Исследователи полны энтузиазма, и будущее представляется им наполненным светом… и цветом.
Но это — совсем другая история.
Литература:
#феомеланин Instagram posts — Gramho.com
Добрый вечер, дорогие мои !🍰☕🌸Как прошёл ваш день, чем порадовал ?
⠀
А я сегодня закончу обсуждение рыжих. Кстати , напишите в комментариях , что ещё хотели бы узнать в акушерстве и гинекологии, я подготовлю интересные посты 👍Расскажите, как вы относитесь к рыжим , а если сами — натурально рыжие, как вы переносите боль, как у вас заживают ранки и царапины ?
⠀
Не забывайте про ❤- это лучшая оценка моего труда 👌
В прошлом посте мы остановились на том , что рыжие лучше вырабатывают витамин Д.
Низкая концентрация тёмного пигмента эумеланина создает благоприятные условия, при которых может вырабатываться большое количество витамина Д даже при небольшом количестве солнечного света.
⠀
Однако, при сильном УФ-излучении (как в регионах близких к экватору) более низкая концентрация меланина приводит к некоторым негативным последствиям, например, высокому риску рака кожи.
Рыжие лучше воспринимают солнечные лучи и вырабатывают собственный витамин Д более интенсивно, отчасти за счёт 1 и 2 фототипов кожи.
⠀
Однако , как и всем нам , рыжим тоже необходимо защищать кожу от избытка солнечных лучей.
В своих недавних постах я подробно написала о роли витамина Д в жизни человека ( #дпвитаминД), его участии в процессе работы костного аппарата, иммунной и нервной систем.
⠀
☝🏻Положительный момент : у рыжих реже возникают некоторые типы рака, например рак яичка, что тоже связано с защитным действием витамина Д.
У рыжих за счёт повышенной выработки витамина Д также реже развивается остеопороз и рахит.
⠀
❗Рыжий цвет является самым редким цветом волос у людей. Несгорающая кожа, связанная с рыжим цветом волос , может быть преимуществом в северных странах, где солнечный свет является редкостью. Исследования Бодмера и Кавалли-Сфорца дали возможность предположить, что светлая кожа предотвращает развитие рахита в странах с холодным климатом, способствуя высокому уровню выработки витамина D, и также позволяет человеку сохранять тепло лучше, чем человеку с темным цветом кожи.
⠀
❗Меланин, в избытке содержащийся в коже, препятствует выработке
витамина Д, поэтому у афроамериканцев наблюдается дефицит витамина Д.
⠀
Продолжение в карусели👉👉👉
Цвет – причина бед. О чем расскажут ваши волосы — ЗдоровьеИнфо
Цвет волос часто связывают с каким-то определенным набором личных качеств. Но, помимо этого, он также может многое рассказать о вашей физиологии и предрасположенности к заболеваниям.
Цвет волос определяется содержанием в них двух пигментов — эумеланина и феомеланина.
Последний имеет красноватый оттенок и, в отличие от тёмного и зернистого меланина, его молекулы не образуют гранул (распределены диффузно). Если синтезируется большое количество эумеланина, то цвет волос становится темным — коричневым (если в достаточном количестве присутствует феомеланин) или чёрным (если эумеланина очень много, а феомеланина очень мало или нет).
Исследование: Великобритания, 2020 год, 205 354 мужчин, мужчины с темным цветом волос имели риск более раннего пубертата, это было связано с более высоким гипертонии и сахарного диабета в дальнейшем, что связывали с более короткой продолжительностью жизни.
Механизм: Цвет волос и половое созревание связаны через гипофиз, так как он выделяет гонадотропный гормон, отвечающий за созревание половых желез, и меланотропный гормон, отвечающий за стимуляцию синтеза и секреции меланинов (меланогенез) клетками-меланоцитами кожи и волос, а также пигментного слоя сетчатки глаза.
Соответствующая большая продолжительность жизни связана с более светлым цветом волос.
Совет: наблюдаться у врача, измерять давление, уровень глюкозы крови
Подвержены никотиновой зависимости: меланин снижает активность печеночных ферментов, поэтому никотин дольше циркулирует в организме
Никотин аккумулируется в тканях, содержащих меланин, и чем больше меланина содержится в тканях, тем медленнее никотин будет выводиться из организма, а значит быстрее вызывать зависимость.
Исследование: Великобритания, 2013 год, 1000 мужчин. По данным опроса 54% мужчин предпочитают брать в жены брюнеток, 13% – блондинок и 30% не имеют предпочтений.
Почему волосы могут быть рыжими?
Цвет волос определяется содержанием в них двух пигментов — эумеланина и феомеланина. Рыжий цвет волос — результат очень большого количества феомеланина и почти полного отсутствия эумеланина.
Рыжий цвет волос связан с наличием мутации гена MC1R. Он заставляет клетки активно производить красноватый тип меланина — феомеланин. Учёные предполагают, что этот ген появился ещё у неандертальцев, населявших Европу 200 тысяч лет назад.
Наличие двух копий этого гена запускает выработку высокого уровня красного пигмента феомеланина и снижает уровень темного пигмента эумеланина, что приводит к классической светлой коже, веснушкам, светлым глазам и рыжим волосам.
Рыжие волосы и болезнь паркинсонаНаличие мутации гена MC1R кроме рыжего цвета волос кодирует также тонкую кожу и выработку дофамина. Снижение выработки дофамина может быть в дальнейшем связано с возникновением болезни Паркинсона.
Рыжие волосы и меланомаЛюди с рыжими волосами, светлой, тонкой кожей и плохой способностью к загару имеют более высокий риск развития меланомы. Они часто несут варианты рецептора меланокортина-1 (MC1R), который имеет пониженную способность вызывать пигментацию по сравнению с более распространенными формами MCR1.
Рыжий цвет волос связан с высоким уровнем витамина DНосители рыжих волос почти всегда имеют светлую кожу — это является генетическим преимуществом в климатических зонах, где большую часть года стоит холодная погода, идёт много дождей. В таких местах Земли мало солнечных дней, и тем, кто там живёт, важно получать достаточное количество витамина D.
Рыжий цвет волос и рак простатыИсследование: США и Финляндия, 2013 год, 20 863 мужчин, Фенотип рыжих волос, который является результатом полиморфизма гена рецептора меланокортина-1 (MC1R), связан с более низким риском рака простаты.
Почему волосы могут быть светлыми?
Цвет волос определяется содержанием в них двух пигментов — эумеланина и феомеланина. Светлыми волосы становятся, если феомеланин синтезируется в сравнительно малых порциях, а эумеланин практически не вырабатывается.
Что такое макулярная дегенерация?
Это прогрессирующее заболевание глаз, которое приводит к снижению остроты зрения за счет поражения центрального отдела сетчатки глаза – макулы (в ней, плотно прилегая, друг к другу, располагается множество колбочек и палочек).
Чаще всего макулярная дегенерация встречается у женщин со светлыми волосами и голубыми глазами. Это связано с низким количеством пигмента.
Самодиагностика макулярной дегенерации: сетка Амслера
Если вы заметили любые изменения формы линий сетки (искривления, искажения, прерывистость и затуманивание, как в примере справа) немедленно обратитесь к врачу.
Совет: носить солнцезащитные очки в любое время году.
Светлый цвет волос связан с малым синтезом меланина. Меланины поглощают ультрафиолетовые лучи, и тем самым защищают ткани глубоких слоёв кожи от лучевого повреждения. При низком его количество повышается риск развития меланомы – злокачественной опухоли, развивающейся из меланоцитов — пигментных клеток, продуцирующих меланины.
Совет: наносить крем с SPF не менее 30.
эумеланин и феомеланин волос — 8 рекомендаций на Babyblog.ru
Примечание редактора. Очень важно помнить, что кормление грудью это не теория, а практика. Научные данные, которые появляются каждый день, всего лишь объясняют то, что кормящие матери уже давно узнали опытным путем за многие столетия кормления грудью. Кормление — это отношения между матерью и ребенком, взаимосвязанная система, которая работает, когда и мать, и ребенок учатся понимать друг друга. Смотрите на ребенка, и вы никогда не ошибетесь!
Научные данные отвечают на наши вопросы, но не всегда верны. Знания об анатомии груди, не говоря уже о физологии лактации, меняются даже сегодня. Всего лишь недавно австралийские ученые опровергли знания о строении лактирующей груди, которые господствовали целых 160 лет!
Посмотреть чем отличаются старые представления об анатомии лактирующей груди от новых.
Основые положения: (1) млечные протоки разветвляются ближе к соску; (2) млечные пазухи не существуют; (3) железистая ткань располагается ближе к соску; (4) у основания соска почти нет подкожного жира. Соотношение железистой ткани к жиру составляет 2:1. 65% всей железистой ткани находится в радиусе 30мм от основания соска. В соске есть 4-18 млечных протоков. Сложная система протоков не симметрична и не радиальна (Medela 2006).
Многие из нас знают, что кормление грудью — это и кормление, нормальная детская еда, и удобный способ любить, воспитывать и заботиться о ребенке. А знаете ли вы, как работает кормящая грудь, как в ней появляется молоко? Ребенок высосал все молоко, а грудь опять наполнилась. Почему после опустошения грудь снова наполняется? Что думали об этом наши предки? Что нам известно сегодня? Ответы на все эти вопросы вы найдете в этой статье. Когда вы узнаете, как работает грудь кормящей матери, вы еще больше станете ценить удивительный процесс грудного вскармливания, кормящую грудь и кормящих матерей, которые питают новую жизнь вне утробы.
Из истории
На протяжении тысяч лет людей интересовала анатомия и физиология груди. Самые ранние медицинские документы о женской груди восходят к древнему Египту. В них описывается, как определить, хорошее у матери молоко или плохое, и как увеличить его количество. Автор рекомендует втирать в спину матери рыбий жир, а ей«сидеть, скрестив ноги… растирая грудь растением мака», чтобы увеличить поток молока (Fildes 1985). Мэрилин Ялом, автор книги «История груди» поясняет: «Как минимум, оба метода помогали матери расслабиться», что, в свою очередь, способствовало приливу молока (рефлекс выброса молока), но скорее всего они не влияли на его выработку. Врач древности Гиппократ (460-377 гг. до н. э.) считал, что менструальная кровь каким-то образом преобразуется в молоко. Эта точка зрения господствовала аж до 17 века! В период Ренессанса , Леонардо да Винчи (1452-1519) в своих анатомических чертежах рисовал вены, соединяющие матку и грудь.
Даже философ Аристотель (384-322 гг. до н. э.) писал о грудном вскармливании. Он считал, что у женщин с темным цветом кожи молоко здоровее, нежели чем у белокожих, и что у детей, которые пили более тёплое материнское молоко, раньше прорезались зубы. (Он был неправ в обоих случаях.) Аристотель также считал, что детям не следует давать пить молозиво. Это заблуждение сих пор сохраняется в некоторых культурах. Соран, гинеколог древности (практиковал в 100-140 гг.), советовал массаж груди и принудительную рвоту как средство для увеличения количества молока. Однако он не советовал пить «напитки с добавлением праха сожженных сов и летучих мышей» (Soranus 1991). К 16 столетию открытия об анатомии груди стало двигаться в направлении сегодняшних представлений. Изучения трупов показало, что грудь состоит из железистой ткани, которая, как заключили ученые того времени, «преобразует кровь, идущую к груди по венам, в молоко» (Vesalius 1969).
Во многих ранних документах о грудном вскармливании затронута тема кормилиц: женщин, которых нанимали для того, чтобы кормить грудью чужого ребенка. Кормилицы упоминаются в своде законов Хаммурапи (1700 года до н.э.), Библии, Коране и произведениях Гомера. Существовали чёткие предписания, какими качествами должны обладать лучшие кормилицы: от цвета волос, формы и внешнего вида груди до пола детей кормилицы (Yalom 1997). Начиная с 18 века врачи наконец начали понимать, что для здоровья матери лучше кормить своего ребёнка самой, а не прибегать к услугам кормилицы, и что материнское молозиво полезно для ребёнка (Riordan 2005).
За последние 50 лет медицинской науке стало известно намного больше о женском молоке, особенно в сфере иммунологии. Сегодня известно, что в молозиве содержится огромная концентрация антител, которые защищают новорожденного от болезней; что состав и пропорции питательных веществ в молоке являются эталоном питания младенцев и детей; и что после года, когда ребенок реже сосет грудь, в молоке повышается концентрация иммунных факторов .
Если женщина родила раньше срока, ее молоко отличается по составу от молока женщины, которая родила в срок. Молоко матери недоношенного ребенка приспособлено под нужды столь уязвимого малыша. В книге «Женское искусство грудного вскармливания» написано: «Нет двух матерей с одинаковым молоком …Состав женского молока меняется изо дня в день и отличается даже в зависимости от времени суток…Молозиво, которое высасывает малыш в первый день жизни, отличается от молозива на второй или третий день.»
Женское молоко — сложное живое вещество, которое закладывает фундамент здоровья и оптимального развития маленьких детей.
Развитие груди
Грудь начинает развиваться еще в утробе матери у зародышей и мужского, и женского пола. Между 4 и 7 неделями жизни эмбриона, внешние кожные покровы начинают утолщаться вдоль линии от подмышечной впадины до паховой области. Так формируются молочные складки или молочные линии. Позднее большая часть этих «молочных линий» исчезает, но небольшая часть в области груди остается, и здесь формируются от 16 до 24 зачатков молочной железы, которые развиваются и превращаются в молочные протоки и альвеолы — мешочки, в которых образуется и хранится молоко.
Сначала молочные протоки идут к небольшой впадине под кожей, но вскоре после рождения на этом месте формируется сосок (Sadler 2000). Сосок окружен ареолой. После этого развитие молочной железы приостанавливается вплоть до полового созревания.
Следующая стадия развития молочных желез наступает, когда у девочек начинается период полового созревания, в возрасте приблизительно от 10 до 12 лет. Грудь начинает расти за год или два до начала менструаций. Ткани груди понемногу растут во время каждого овуляторного цикла. Основной рост груди происходит в период полового созревания, но продолжается приблизительно до 35 лет (Riordan 2005). Грудь не считается полностью созревшей до тех пор, пока женщина не родит и не начнет вырабатывать молоко(Love & Lindsey 1995).
В книге «Грудное вскармливание.
Вопросы и ответы.» (The BREASTFEEDING ANSWER BOOK) написано, что зрелая грудь состоит из железистой ткани для выработки и перемещения молока; поддерживающей соединительной ткани; крови, доставляющей питательные вещества, необходимые для производства молока; лимфы — жидкости, которая выводит побочные отходы через лимфатическую систему организма; нервов, которые посылают сигналы в головной мозг; и жировой ткани, которая защищает от повреждений (Mohrbacher & Stock 2003). Железистая ткань состоит из альвеол, в которых вырабатывается и хранится молоко до тех пор, пока окружающие их мышечные клетки не вытолкнут молоко в малые (альвеолярные) протоки. Малые протоки далее сливаются в более крупные протоки, которые открываются в 5 -10 млечных порах на кончике соска. До недавнего времени считалось, что помимо альвеол, молоко также хранится в млечных пазухах (lactiferous sinuses), расширениях протоков перед самым соском. Однако недавние ультразвуковые исследования показали, что млечные пазухи не являются постоянными структурами груди (Kent 2002) . Молочные протоки под соском расширяются под воздействием рефлекса выделения молока, но вновь сужаются после окончания кормления, когда оставшееся молоко возвращается обратно в альвеолы. (Прим.редактора. Последние исследования показывают, что млечные пазухи вообще не существуют (Ramsey, Kent 2005)).
Строение груди можно сравнить с деревом. Альвеолы — это листья, протоки — ветви. Множество маленьких веток сливаются и образуют несколько больших ветвей, которые, в свою очередь, формируют ствол. Подобно ветвям дерева, грудь состоит из долек, каждая из которых сформирована из одного большого протока с множеством малых протоков и соединенных с ними альвеол. Большинство специалистов считают, что у женщин от 15 до 20 таких долей в каждой груди, однако одно из недавних исследований утверждает, что их скорее 7-10 в каждой груди (Kent 2002).
Ареола или околососковый кружок, темная область вокруг соска, получает такую окраску из-за пигментов эумеланина и феомеланина.
На ареоле расположены сальные железы (выделяющие жир, который смягчает и защищает кожу), потовые железы, и железы Монтгомери, которые выделяют вещество, смазывающее сосок и защищающее его от бактерий.
Беременность и лактация
Во время беременности грудь сильно меняется под воздействием гормонов беременности, которые включают эстроген, прогестерон, пролактин. Каждый гормон играет свою особую роль в подготовке организма к грудному вскармливанию. Самое заметное изменение — это увеличение груди. Во время первого триместра беременности с большой скоростью разрастаются и ветвятся протоки и альвеолы. Многие женщины отмечают, что грудь стала более чувствительной.
Лактогенез — термин для описания начала лактации. Существуют три стадии лактогенеза. Первая стадия начинается приблизительно за 12 недель до родов, когда молочные железы начинают вырабатывать молозиво. Грудь увеличивается еще больше, так как альвеолы наполняются молозивом, но из-за высокого уровня прогестерона в крови матери молоко не вырабатывается в полном объёме до рождения ребенка.
Вторая стадия лактогенеза начинается после рождения или отделения плаценты. Уровень прогестерона падает, в то время как уровень пролактина остаётся высоким. Пролактин — главный гормон лактации. Он вырабатывается под воздействием гормнов гипофиза, щитовидной железы, надпочечников, яичников и поджелудочной железы. К груди приливает больше крови, богатой кислородом. Через 2-3 дня после родов «приходит молоко». Количество молока быстро увеличивается, меняется состав молока: молозиво постепенно сменяется «зрелым» молоком. Количество натрия, хлора и белка в молоке уменьшается, а объём лактозы и других питательных веществ увеличивается. Цвет из золотисто-желтого, типичного цвета молозива, постепенно превращается в голубовато-белый. Так как в этой стадии лактогенеза выработка молока просходит под воздействием гормонов, молоко в груди вырабатывается независимо от того, кормит мать, или нет. В это время очень важно кормить часто (и/или сцеживаться, если ребенок не берет грудь или плохо сосёт), так как считается, что частые кормления в первую неделю после родов увеличивают число пролактиновых рецепторов в груди.
Рецепторы распознают определенный гормон и реагируют на него. Чем больше пролактиновых рецепторов, тем более чувствительны молочные железы к пролактину, что, по мнению исследователей, влияет на количество молока у матери на следующей стадии лактогенеза.
Третья стадия лактогенеза так же известна как молокообразование. На этой стадии устанавливается выработка зрелого молока. Теперь молоко вырабатывается не под воздействием гормонов (эндокринный контроль), а под аутокринным контролем. Это означает, что дальнейшая выработка молока зависит больше от того, насколько опустошается грудь, а не от уровня гормонов в крови. Молоко вырабатывается по принципу «спрос рождает предложение», а именно чем больше мать кормит грудью, т.е. чем больше сосет ребенок, тем больше будет молока. И соответственно, чем меньше кормить, тем меньше будет молока.
Физиология и количество молока
Представление о процессе выработки молока может помочь матери организовать грудное вскармливание так, чтобы малышу всегда хватало молока. Например, иногда женщина ощущает, что ребенок полностью опустошил грудь, и в ней совсем ничего не осталось, хотя ребёнок еще не наелся. Если мама знает, что молоко постоянно вырабатывается в альвеолах, она с уверенностью будет давать ребёнку грудь, даже если она кажется «пустой». В ходе одного исследования было обнаружено, что за сутки дети в среднем высасывают только 76% молока, которое на данный момент находится в груди (Hartmann et al.1993)
Выработка молока зависит от того, как опустошается грудь. Когда ребёнок сосёт грудь, в мозг матери поступает сигнал, который провоцирует выработку гормона окситоцина. Выброс окситоцина в кровь приводит к сокращению мышечных клеток вокруг альвеол, в результате чего молоко выталкивается по протокам к соску. Это и есть рефлекс выброса молока. В этот момент женщина может почувствовать покалывание в груди или ощущают, как приливает молоко, поэтому этот рефлекс называется приливом. Во время прилива альвеолы опустошаются, и молоко поступает к соску, откуда его и высасывает ребенок.
Когда альвеолы пусты, в них вырабатывается больше молока. В результате недавних исследований было выявлено, что в женском молоке содержится органическое соединение под названием «ингибитор лактации по типу обратной связи», который регулирует выработку молока (Wilde 1995). Когда в груди много молока, этот белок дает сигнал альвеолам, чтобы они перестали вырабатывать молоко. После того, как ребенок опустошил грудь, и, следовательно, в ней нет больше «ингибитора лактации», который останавливает выработку молока, альвеолы снова начинают вырабатывать молоко. Именно поэтому для оптимального количества молока так важно часто прикладывать ребёнка к груди и давать ему максимально опустошать грудь.
Еще один фактор, который влияет на количество молока — накопительная вместимость груди. Иногда женщины с маленькой грудью волнуются, что у них будет мало молока. Эти переживания напрасны: количество молока не зависит от размера груди. Возможно, между кормлениями в маленькой груди может храниться не так много молока, как в большой, но если часто прикладывать ребенка к груди, молока будет ровно столько, сколько нужно ребёнку. Женщины с большей грудью и большей накопительной вместимостью груди могут позволить себе кормить реже, и это, возможно, не повлияет на количество молока. С другой стороны, некоторым женщинам с маленькой грудью нужно кормить чаще, так как у них грудь наполняется быстрее, а выработка молока замедляется по мере заполнения альвеол. Частые кормления не только положительно влияют на количество молока, это также хорошая профилактика застоев и инфекций груди.(Прим. редактора. Исследования показывают, что «внешний размер груди не был надежным показателем количества молока и вместимости груди, и что у всех женщин вырабатывалось достаточно молока за сутки» [вне зависимости от размера груди]).
Нужно ли маме знать, сколько молока помещается в её груди в одно кормление, чтобы определить, как часто ей следует кормить малыша? Однозначно нет. Здоровые дети высасывают ровно столько молока, сколько им надо и когда надо, при этом мамам даже не надо ломать голову о том, что при этом происходит в груди.
Представление о том, как работает кормящая грудь может пригодится лишь в случаях, когда женщине нужно разобраться почему у нее не хватает молока. Кроме того, эти знания помогут женщине проанализировать мифы и заблуждениям о грудном вскармливании. Например, она будет знать, что ей не нужно ждать между кормлениями, пока её грудь «наполнится» — в груди всегда есть молоко. Теория станет хорошим подспорьем и в случаях, когда ребенок кажется голодным, или у него скачок роста: женщина уверенно покормит лишний раз, т.к. знает, что более частые кормления практически сразу же ускорят выработку молока.
Как разные вещества попадают в грудное молоко?
Представление о механизме выработки молока помогает матери понять, как различные вещества (белки, а также вредные вещества или лекарства) проникают в молоко. Это поможет женщине решить, как питаться, лечиться, какой образ жизни вести, когда она кормит грудью.
Как же разные вещества попадают в молоко? Когда женщина принимает лекарство или ест пищу, они расщепляются в желудочно-кишечном тракте (ЖКТ), а затем уже молекулы этих веществ всасываются в кровь. Вместе с кровью молекулы попадают в капилляры грудной ткани, где они проникают в молоко через клетки, выстилающие альвеолы. Этот процесс называется диффузия.
Так разные составляющие молока, а также лекарственные препараты и другие вещества, попадают в молоко. Однако попадёт ли то или иное вещество в молоко, и в каком количестве, зависит от многих факторов. В первые дни после родов между лактоцитами, клетками, которые выстилают альвеолы и блокируют или пропускают разные вещества, есть промежутки. Поэтому в первые дни после родов вещества могут проникать в молоко более свободно. Спустя несколько дней лактоцитные промежутки закрываются. С этого момента разным веществам сложнее проникнуть через барьер между кровью и молоком (гематомолочный барьер).
Благодаря процессу диффузии в молозиво и зрелое молоко поступают различные полезные составляющие, например, антитела.
Антитела — это белковые молекулы, которые входят в состав крови и помогают организму бороться с инфекцией. В женском молоке самая высокая концентрация антител бывает в начале и в конце лактации. Очень важные антитела — секреторные иммунноглобулины А(SIgA) — синтезируются и хранятся в груди. Помимо SIgA в молоке есть около 50 антибактериальных факторов, многие из которых попадают туда из материнской крови. И это не включая тех факторов, которые еще не обнаружены! Антитела и антибактериальные факторы — одно из важнейших преимуществ грудного вскармливания. Все женщины передают своим малышам антитела во время беременности и родов, но грудное вскармливание помогает матери ещё дольше защищать малыша от болезней.
В результате диффузии в грудное молоко попадают и вещества, которые могут беспокоить ребенка. Многие считают, что если мама съест газообразующую пищу, например, капусту (разные виды), малыша тоже будет пучить. Правда ли это? Нет. Сами газы не проникают в кровь из ЖКТ, а значит не попадают и в молоко. Однако в процессе переваривания пищи некоторые белки из еды попадают в кровь, а затем в молоко. Некоторые малыши реагируют на определённые виды белка: у них пучит животик, они беспокоятся. Если мама заметила, что после употребления какой-то определенной пищи у малыша возникает такая реакция, можно попробовать временно исключить этот конкретный продукт из питания. Тут особенно важно заметить, что у большинства детей причина беспокойства и газообразования кроется в чём-то другом. Аллергические реакции на отдельные вещества в материнском молоке проявляются в виде раздражений на коже, респираторных проблем и проблем ЖКТ. Если в семье кто-то страдает аллергией на определенные продукты, маме стоит воздержаться от них на период грудного вскармливания.
Что все это значит для кормящей мамы? Кормящая мать может есть всё, что пожелает и может быть уверена, что большинство детей никак не реагируют на то, что едят из мамы. (Более подробно в статье «Аллергии и семья грудного ребенка» в издании журнала New Beginnings за Июль-Август 1998.)
ДиффузияЛекарства, которые принимает кормящая мать, также могут проникнуть через лактоцитарный барьер из крови в альвеолы. Автор книги «Лекарственные препараты и материнское молоко» Томас Хейл пишет, что существует несколько факторов, которые влияют на попадание лекарственных препаратов в молоко. Концентрация медикамента в крови матери влияет на количество лекарства, которое попадёт в молоко. Если в крови высокая концентрация лекарства, в молоко, где концентрация его ниже, в процессе диффузии, попадёт больше лекарства. В процессе диффузии концентрация веществ поддерживается на одном уровне по обе стороны барьера. Поэтому, по мере того, как концентрация определённого вещества будет снижаться в крови матери, частицы этого же вещества, которые попали в молоко, будут возвращаться в кровь, и его концентрация в молоке также снизится. (Прим. ред. Как узнать, когда в молоке больше всего какого-то вещества? Это можно определить, если знать время максимальной концентрации (Tmax) лекарства в крови. Обычно эта информация есть в любом фармакологическом справочнике. Практически это значит, что кормления можно спланировать так, чтобы не кормить в то время, когда концентрация лекарства в крови самая высокая.)
Почему важно понимать процесс диффузии? Некоторые мамы ошибочно думают, что после того как они выпьют бокал вина, алкоголь будет в молоке, до тех пор, пока они его не сцедят. В результате она сомневаются, кормить ли ребёнка или сцедить и вылить молоко. На самом деле, уровень алкоголя в молоке снизится тогда же, когда и в крови. У женщины весом 54 килограмма количество алкоголя, которое содержится в одном бокале вина или пива, исчезнет из крови в течение 2-3 часов. Через то же самое время алкоголя не останется в молоке. (Прим. ред. Определить, когда концентрация вещества в молоке снижается, можно заглянув в фармакологический справочник. Период полувыведения (T1/2) обозначает промежуток времени, в течение которого концентрация препарата в организме снижается на 50%.)
На степень попадания лекарства в молоко матери также влияет молекулярный вес (фактически величина молекулы) вещества, из которого состоит лекарство, cвязывание с белками и жирорастворимость. Вещества с малым молекулярным весом легче проникают в молоко. (Прим.ред. Вещества с молекулярным весом меньше 200 легко проникают в молоко. Если большая часть препарата связывается с белками, лекарство не может проникнуть в молоко, т.к. лекарство «приклеено» к белку, и в плазме нет свободных молекул лекарства, которые могли бы легко проникнуть в молоко, если бы они не были связаны с белками. В молоке содержится больше жиров, чем в плазме, поэтому жирорастворимые препараты могут концентрироваться в молочных жирах. В книге«Лекарственные препараты и материнское молоко» Т. Хейл пишет, что большинство лекарств совместимы с грудным вскармливанием. Если же какое-то лекарство несовместимо с кормлением, почти всегда ему можно найти подходящую замену. Если женщине надо принимать лекарства, ей стоит проконсультироваться с врачом. ( Более подробно в статье «Лекарственная терапия и кормящая мать» в издании журнала New Beginnings за ноябрь-декабрь 2003.)
Анатомия груди кормящей матери
Автор: Анна Эдгар
Себринг, Флорида, США Из журнала NEW BEGINNINGS, изд. 22, №2, Март-Апрель 2005, стр. 44-50
Перевод Виктории Худяковой при участии Марии Сорокиной
Редакция перевода Наталии Гербеда-Уилсон
Корректор Алеся Брижань
Информация взята с сайта
Меланин — Melanin — qaz.wiki
Группа натуральных пигментов, содержащихся в большинстве организмов
| Имена | |
|---|---|
| Предпочтительное название IUPAC 3,8-Диметил-2,7-дигидробензо [1,2,3- cd : 4,5,6- c ‘ d ‘] дииндол-4,5,9,10-тетрон | |
| Идентификаторы | |
| ChemSpider | |
| Характеристики | |
| C 18 H 10 N 2 O 4 | |
| Молярная масса | 318,288 г · моль -1 |
| Плотность | От 1,6 до 1,8 г / см 3 |
| Температура плавления | <-20 ° С (-4 ° F, 253 К) |
| Точка кипения | От 450 до 550 ° C (от 842 до 1022 ° F; от 723 до 823 K) |
| Ссылки на инфобоксы | |
Химическое соединение
Микрофотография пигмента меланина (светопреломляющий гранулированный материал — центр изображения) в пигментированной меланоме . Микрофотография эпидермиса с меткой меланина слева.Меланин ( ɛ л ə п ɪ п / ( слушать ) , от греческого : μέλας Мелас , «черный, темный») представляет собой общий термин для группы природных пигментов можно найти в большинстве организмов . Меланин производится через многоступенчатый химический процесс , известный как меланогенез , где окисление на аминокислоты тирозина следует полимеризация . Пигменты меланина производятся в специальной группе клеток, известной как меланоциты .
Существует пять основных типов меланина: эумеланин , феомеланин , нейромеланин , алломеланин и пиомеланин. Самым распространенным типом является эумеланин, который бывает двух типов: коричневый эумеланин и черный эумеланин. Феомеланина является цистеином -производным , который содержит поли бензотиазин часть, которые в значительной степени ответственны за цвет красных волос , среди другой пигментации. Нейромеланин находится в головном мозге . Было проведено исследование его эффективности при лечении нейродегенеративных расстройств, таких как болезнь Паркинсона . Алломеланин и пиомеланин — это два типа безазотистого меланина.
В коже человека меланогенез инициируется воздействием УФ-излучения , в результате чего кожа темнеет. Меланин — эффективный поглотитель света; пигмент способен рассеивать более 99,9% поглощенного УФ-излучения. Из-за этого свойства считается, что меланин защищает клетки кожи от повреждения УФ-излучением , снижая риск истощения фолиевой кислоты и деградации дермы, и считается, что воздействие УФ-излучения связано с повышенным риском злокачественной меланомы , рака меланоцитов ( клетки меланина). Исследования показали меньшую заболеваемость раком кожи у людей с более концентрированным меланином, т. Е. Более темным оттенком кожи . Однако связь между пигментацией кожи и фотозащитой все еще не ясна.
Люди
У людей меланин является основным фактором, определяющим цвет кожи . Он также содержится в волосах , пигментированные ткани , лежащие в основе радужной оболочки глаза, и бороздка vascularis из внутреннего уха . В головном мозге ткани с меланином включают мозговое вещество и нейроны, несущие пигмент, в областях ствола мозга , таких как голубое пятно . Это также происходит в ретикулярной зоне надпочечников .
Меланина в коже вырабатывается меланоцитов , которые находятся в базальном слое из эпидермиса . Хотя в целом люди обладают одинаковой концентрацией меланоцитов в коже, у некоторых людей и этнических групп меланоциты производят различное количество меланина. У некоторых людей в организме очень мало или совсем отсутствует синтез меланина — состояние, известное как альбинизм .
Поскольку меланин представляет собой совокупность более мелких компонентных молекул, существует много различных типов меланина с разными пропорциями и схемами связывания этих компонентных молекул. И феомеланин, и эумеланин содержатся в коже и волосах человека, но эумеланин является наиболее распространенным меланином у людей, а также формой, которая, скорее всего, будет дефицитной при альбинизме.
Эумеланин
Входит в структурную формулу эумеланина. «(COOH)» может быть COOH или H или (реже) другими заместителями . Стрелка указывает, где продолжается полимер.Эумеланин полимеры уже давно мысль включает в себя многочисленный сшитый 5,6-дигидрокси индол ( DHI ) и 5,6-дигидроксииндол-2- карбоновой кислоты ( DHICA ) полимеры.
Существует два типа эумеланина: коричневый эумеланин и черный эумеланин. Эти два типа эумеланина химически отличаются друг от друга характером полимерных связей. Небольшое количество черного эумеланина при отсутствии других пигментов вызывает седину. Небольшое количество коричневого эумеланина при отсутствии других пигментов вызывает желтые (светлые) волосы. По мере старения организм продолжает вырабатывать черный эумеланин, но перестает вырабатывать коричневый эумеланин, что приводит к появлению седых волос, характерных для пожилых людей. [Этому объяснению противоречит ссылка, процитированная для этого параграфа, то есть Ito and Wakamatsu 2011. Этот параграф следует удалить.]
Феомеланин
Входит в структурную формулу феомеланина. «(COOH)» может быть COOH или H или (реже) другими заместителями . Стрелки указывают, где продолжается полимер.Феомеланины (или феомеланины) придают от желтоватого до красноватого цвета. Феомеланины особенно сконцентрированы в губах, сосках, головке полового члена и влагалище. Когда небольшое количество коричневого эумеланина в волосах, которое в противном случае привело бы к появлению светлых волос, смешивается с красным феомеланином, в результате получаются оранжевые волосы, которые обычно называют «красными» или «рыжими» волосами . Феомеланин также присутствует в коже, и, следовательно, у рыжих часто бывает более розоватый оттенок кожи.
С химической точки зрения феомеланины отличаются от эумеланинов тем, что структура олигомера включает бензотиазиновые и бензотиазольные звенья, которые образуются вместо DHI и DHICA , когда присутствует аминокислота L-цистеин .
Трихохромы
Трихохромы (ранее называемые трихосидеринами) — это пигменты, производимые тем же метаболическим путем, что и эумеланины и феомеланины, но в отличие от этих молекул они имеют низкую молекулярную массу. Они встречаются в некоторых рыжих человеческих волосах.
Нейромеланин
Нейромеланин (НМ) — это темный нерастворимый полимерный пигмент, вырабатываемый в определенных популяциях катехоламинергических нейронов головного мозга. У людей наибольшее количество ЯМ, которое присутствует в меньших количествах у других приматов и полностью отсутствует у многих других видов. Биологическая функция остается неизвестной, хотя было показано, что человеческий НМ эффективно связывает переходные металлы, такие как железо, а также другие потенциально токсичные молекулы. Следовательно, он может играть решающую роль в апоптозе и связанной с ним болезни Паркинсона .
Другие организмы
Меланины выполняют очень разные роли и функции в разных организмах. Форма меланина составляет чернила, используемые многими головоногими моллюсками (см. Чернила головоногих ) в качестве защитного механизма от хищников. Меланины также защищают микроорганизмы, такие как бактерии и грибки, от стрессов, вызывающих повреждение клеток, таких как УФ-излучение от солнца и активные формы кислорода . Меланин также защищает от повреждений, вызванных высокими температурами, химическими воздействиями (такими как тяжелые металлы и окислители ) и биохимическими угрозами (такими как защита хозяина от вторгшихся микробов). Следовательно, у многих патогенных микробов (например, у Cryptococcus neoformans , грибка) меланины, по-видимому, играют важную роль в вирулентности и патогенности , защищая микроб от иммунных ответов его хозяина . У беспозвоночных основным аспектом системы врожденной иммунной защиты от вторжения патогенов является меланин. Через несколько минут после заражения микроб инкапсулируется в меланине (меланизация), и считается, что образование побочных продуктов свободных радикалов во время образования этой капсулы помогает их убить. Некоторые типы грибов, называемые радиотрофными грибами , по-видимому, могут использовать меланин в качестве фотосинтетического пигмента, который позволяет им улавливать гамма-лучи и использовать эту энергию для роста.
Более темные перья из птиц обязаны своим цветом меланина и менее легко разлагаются бактериями , чем непигментированных те или те , которые содержат каротиноиды пигменты. Перья, содержащие меланин, также на 39% более устойчивы к истиранию, чем перья, которые не содержат, потому что гранулы меланина помогают заполнить пространство между кератиновыми прядями, которые образуют перья. Синтез феомеланина у птиц подразумевает потребление цистеина, полузаменимой аминокислоты, которая необходима для синтеза антиоксидантного глутатиона (GSH), но может быть токсичной, если содержится в избытке в рационе. Действительно, хищные птицы, которые имеют высокое содержание белка в рационе, демонстрируют окраску на основе феомеланина.
Меланин также важен для пигментации млекопитающих . Рисунок шерсти млекопитающих определяется геном агути, который регулирует распределение меланина. Механизмы гена были тщательно изучены на мышах, чтобы дать представление о разнообразии структур шерсти млекопитающих.
Наблюдалось, что меланин у членистоногих откладывается слоями, создавая брэгговский отражатель с переменным показателем преломления. Когда масштаб этого рисунка совпадает с длиной волны видимого света, возникает структурная окраска , придающая ряду видов переливающийся цвет.
Паукообразные — одна из немногих групп, в которых меланин обнаружить нелегко, хотя исследователи обнаружили данные, свидетельствующие о том, что пауки действительно производят меланин.
Некоторые виды бабочек, в том числе лесная тигровая , превращают ресурсы в меланин, чтобы улучшить свою терморегуляцию. Поскольку у древесной тигровой бабочки есть популяции в большом диапазоне широт, было замечено, что более северные популяции показали более высокие темпы меланизации. Как у желтых, так и у белых самцов лесной тигровой моли, особи с большим количеством меланина имели повышенную способность улавливать тепло, но повышенный уровень хищничества из-за более слабого и менее эффективного апосематического сигнала.
Растения
Химическая структура индол-5,6-хинонаМеланин, вырабатываемый растениями, иногда называют «катехоловыми меланинами», поскольку они могут давать катехол при плавлении с щелочами. Обычно это проявляется в ферментативном потемнении фруктов, таких как бананы. Меланин скорлупы каштана можно использовать как антиоксидант и краситель. Биосинтез включает окисление индол-5,6-хинона полифенолоксидазой тирозиназного типа из тирозина и катехоламинов, что приводит к образованию катехолового меланина. Несмотря на это, многие растения содержат соединения, подавляющие выработку меланинов.
Биосинтетические пути
L-лейкодопахромПервый этап пути биосинтеза обоих eumelanins и pheomelanins является катализируемой с помощью тирозиназы .
- Тирозин → ДОФА → Допахинон
Допахинон может соединяться с цистеином двумя путями с образованием бензотиазинов и феомеланинов.
- Допахинон + цистеин → 5-S-цистеинилдопа → промежуточный бензотиазин → феомеланин
- Допахинон + цистеин → 2-S-цистеинилдопа → промежуточный бензотиазин → феомеланин
Кроме того, допахинон может быть преобразован в лейкодопахром и пройти еще два пути к эумеланинам.
- Допахинон → лейкодопахром → допахром → 5,6-дигидроксииндол-2-карбоновая кислота → хинон → эумеланин
- Допахинон → лейкодопахром → допахром → 5,6-дигидроксииндол → хинон → эумеланин
Подробные метаболические пути можно найти в базе данных KEGG (см. Внешние ссылки ).
Микроскопический вид
Меланин коричневый, непреломляющий и мелкозернистый с отдельными гранулами, имеющими диаметр менее 800 нанометров. Это отличает меланин от обычных пигментов разрушения крови , которые крупнее, крупнее и преломлются, а их цвет варьируется от зеленого до желтого или красно-коричневого. В сильно пигментированных поражениях плотные агрегаты меланина могут скрывать гистологические детали. Разбавленный раствор перманганата калия — эффективный отбеливатель меланина.
Генетические нарушения и болезненные состояния
Существует около девяти типов кожно-глазного альбинизма , который в основном является аутосомно-рецессивным заболеванием. У некоторых этнических групп более высокая заболеваемость различными формами. Например, наиболее распространенный тип, называемый глазно-кожным альбинизмом 2 типа (OCA2), особенно часто встречается среди лиц чернокожего африканского происхождения и белых европейцев. Люди с OCA2 обычно имеют светлую кожу, но часто не такие бледные, как OCA1. У них от бледно-русых до золотистых, клубнично-русых или даже каштановых волос и чаще всего голубые глаза. 98,7–100% современных европейцев являются носителями производного аллеля SLC24A5, известного причины несиндромного окулокожного альбинизма. Это аутосомно-рецессивное заболевание, характеризующееся врожденным уменьшением или отсутствием пигмента меланина в коже, волосах и глазах. По оценкам, частота OCA2 среди афроамериканцев составляет 1 из 10 000, что контрастирует с частотой 1 из 36 000 среди белых американцев. В некоторых африканских странах частота заболевания еще выше — от 1 из 2000 до 1 из 5000. Другая форма альбинизма, «желтый глазокожный альбинизм», по-видимому, более распространена среди амишей , которые имеют преимущественно швейцарское и немецкое происхождение. У людей с этим вариантом IB обычно белые волосы и кожа при рождении, но в младенчестве быстро развивается нормальная пигментация кожи.
Глазной альбинизм влияет не только на пигментацию глаз, но и на остроту зрения. Люди с альбинизмом обычно плохо проходят тесты, в диапазоне от 20/60 до 20/400. Кроме того, две формы альбинизма, примерно одна из 2700 наиболее распространенных среди людей пуэрториканского происхождения, связаны со смертностью, не считая смертей, связанных с меланомой.
Связь между альбинизмом и глухотой хорошо известна, но плохо изучена. В 1859 году трактат О происхождении видов , Чарльз Дарвин заметил , что «кошки , которые полностью белые и голубые глаза , как правило , глухие». У людей гипопигментация и глухота встречаются вместе в редком синдроме Ваарденбурга , который преимущественно наблюдается у хопи в Северной Америке . Заболеваемость альбинизмом у индейцев хопи оценивается примерно в 1 из 200 человек. Подобные образцы альбинизма и глухоты были обнаружены у других млекопитающих, включая собак и грызунов. Однако недостаток меланина как таковой , по-видимому, не является прямой причиной глухоты, связанной с гипопигментацией, поскольку у большинства людей, у которых отсутствуют ферменты, необходимые для синтеза меланина, слуховая функция нормальная. Вместо этого отсутствие меланоцитов в сосудистой полоске внутреннего уха приводит к нарушению улитки , хотя причины этого не совсем понятны.
При болезни Паркинсона, расстройстве, которое влияет на нейромоторное функционирование, наблюдается снижение нейромеланина в черной субстанции и голубом пятне как следствие специфического выпадения дофаминергических и норадренергических пигментированных нейронов. Это приводит к снижению синтеза дофамина и норадреналина . Хотя не сообщалось о корреляции между расой и уровнем нейромеланина в черной субстанции, значительно более низкая частота болезни Паркинсона у чернокожих, чем у белых, «подтолкнула некоторых к предположению, что кожный меланин может каким-то образом служить для защиты нейромеланина в субстанции. черная от внешних токсинов «.
Помимо дефицита меланина, молекулярная масса полимера меланина может быть уменьшена различными факторами, такими как окислительный стресс, воздействие света, нарушение его ассоциации с белками меланосомного матрикса , изменения pH или локальные концентрации ионов металлов. Было предложено снизить молекулярную массу или степень полимеризации глазного меланина , чтобы превратить обычно антиоксидантный полимер в прооксидант . Предполагается, что в своем прооксидантном состоянии меланин участвует в возникновении и прогрессировании дегенерации желтого пятна и меланомы . Разагилин , важный монотерапевтический препарат при болезни Паркинсона, обладает свойствами связывания меланина и свойствами уменьшения опухоли меланомы.
Однако более высокие уровни эумеланина также могут быть недостатком, помимо более высокой предрасположенности к дефициту витамина D. Темная кожа является осложняющим фактором при лазерном удалении винных пятен . Как правило, лазеры эффективны при лечении белой кожи, поэтому они менее эффективны при удалении винных пятен у людей азиатского или африканского происхождения. Более высокие концентрации меланина у темнокожих людей просто рассеивают и поглощают лазерное излучение, препятствуя поглощению света тканью-мишенью. Аналогичным образом меланин может осложнить лазерное лечение других дерматологических заболеваний у людей с более темной кожей.
Веснушки и родинки образуются в местах локальной концентрации меланина в коже. Они часто ассоциируются с бледной кожей.
Никотин имеет сродство с меланинсодержащими тканями из-за его функции-предшественника в синтезе меланина или его необратимом связывании с меланином. Было высказано предположение, что это лежит в основе повышенной никотиновой зависимости и более низких показателей отказа от курения у лиц с более темным пигментом.
Адаптация человека
Физиология
Меланоциты вставляют гранулы меланина в специализированные клеточные пузырьки, называемые меланосомами . Затем они переносятся в клетки кератиноцитов эпидермиса человека . Меланосомы в каждой клетке-реципиенте накапливаются наверху ядра клетки , где они защищают ядерную ДНК от мутаций, вызванных ионизирующим излучением ультрафиолетовых лучей солнца . В целом люди, чьи предки долгое время жили в регионах земного шара около экватора, имеют в коже большее количество эумеланина. Это делает их кожу коричневой или черной и защищает их от сильного воздействия солнца, которое чаще приводит к меланомам у людей со светлой кожей.
Не все эффекты пигментации благоприятны. Пигментация увеличивает тепловую нагрузку в жарком климате, и темнокожие люди поглощают на 30% больше тепла от солнечного света, чем очень светлокожие люди, хотя этот фактор может быть компенсирован более обильным потоотделением. В холодном климате темная кожа приводит к большей потере тепла за счет излучения. Пигментация также препятствует синтезу витамина D , поэтому в районах с плохим питанием дети с более темной кожей более подвержены рахиту, чем дети со светлой кожей. Поскольку пигментация кажется не совсем полезной для жизни в тропиках, были выдвинуты другие гипотезы о ее биологическом значении, например, вторичное явление, вызванное адаптацией к паразитам и тропическим болезням.
Эволюционное происхождение
Ранние люди приобрели темный цвет кожи около 1,2 миллиона лет назад в результате адаптации к потере волос на теле, которая усилила действие УФ-излучения. До появления бесшерстности у древних людей под шерстью была достаточно светлая кожа, похожая на ту, что есть у других приматов . Самые последние научные данные свидетельствуют о том, что анатомически современные люди эволюционировали в Африке между 200000 и 100000 лет назад, а затем заселили остальной мир в результате одной миграции между 80000 и 50000 лет назад, в некоторых областях скрещиваясь с некоторыми архаическими видами человека ( неандертальцы , денисовцы). , и, возможно, другие). Кажется вероятным, что у первых современных людей было относительно большое количество меланоцитов, продуцирующих эумеланин, которые производили более темную кожу, как у коренных жителей Африки сегодня. Поскольку некоторые из этих коренных народов мигрировали и поселились в регионах Азии и Европы , селективное давление на производство эумеланина уменьшилось в климате, где солнечное излучение было менее интенсивным. Это в конечном итоге привело к нынешнему диапазону цвета кожи человека. Из двух распространенных вариантов генов, связанных с бледной кожей человека, Mc1r , по-видимому, не подвергся положительному отбору, в то время как SLC24A5 подвергся положительному отбору.
Эффекты
Как и люди, мигрировавшие на север, люди со светлой кожей, мигрирующие к экватору, акклиматизируются к гораздо более сильному солнечному излучению. Природа выбирает меньше меланина, когда ультрафиолетовое излучение слабое. Кожа большинства людей темнеет под воздействием ультрафиолета, что дает им дополнительную защиту, когда это необходимо. Это физиологическая цель загара . Темнокожие люди, вырабатывающие больше эумеланина, защищающего кожу, имеют лучшую защиту от солнечных ожогов и развития меланомы, потенциально смертельной формы рака кожи, а также других проблем со здоровьем, связанных с воздействием сильного солнечного излучения , включая фотодеградацию некоторых витаминов, таких как рибофлавины , каротиноиды , токоферол и фолиевая кислота . Некоторые северо-западные европейцы существенно утратили способность загорать в результате ослабления естественного отбора. Их кожа горит и шелушится, а не загорает. Это связано с тем, что они производят дефектную форму кожного белка Mc1r (рецептор меланокортина-1), который необходим для производства меланина. Они находятся в явно невыгодном положении в тропической и субтропической среде. Они не только страдают от дискомфорта, связанного с легкостью обжигания, но и подвергаются гораздо более высокому риску рака кожи; то же самое и с альбиносами.
Меланин в глазах, в радужной оболочке и сосудистой оболочке помогает защитить их от ультрафиолета и высокочастотного видимого света ; люди с серыми, голубыми и зелеными глазами больше подвержены риску заболеваний глаз, связанных с солнцем. Кроме того, линза окуляра желтеет с возрастом, обеспечивая дополнительную защиту. Однако с возрастом хрусталик также становится более жестким, теряя большую часть своей аккомодации — способности изменять форму для фокусировки с дальнего на ближний — ущерб, вероятно, из-за сшивания белков, вызванного воздействием ультрафиолета.
Недавние исследования показывают, что меланин может выполнять не только светозащиту, но и не только защитную функцию. Меланин способен эффективно хелатировать ионы металлов через свои карбоксилатные и фенольные гидроксильные группы, во многих случаях гораздо более эффективно, чем мощный хелатирующий лиганд этилендиаминтетраацетат (ЭДТА). Таким образом, он может служить для изоляции потенциально токсичных ионов металлов, защищая остальную часть клетки. Эта гипотеза подтверждается тем фактом, что потеря нейромеланина, наблюдаемая при болезни Паркинсона, сопровождается увеличением уровня железа в головном мозге.
Физические свойства и технологические применения
Существуют доказательства в поддержку высокосшитого гетерополимера, ковалентно связанного с матриксными каркасными меланопротеинами . Было высказано предположение, что способность меланина действовать как антиоксидант прямо пропорциональна его степени полимеризации или молекулярной массе . Субоптимальные условия для эффективной полимеризации мономеров меланина могут привести к образованию прооксидантного меланина с более низкой молекулярной массой, который является причиной и развитием дегенерации желтого пятна и меланомы . Сигнальных путей , которые активируют меланизации в пигментном эпителии сетчатки (RPE) , также могут быть вовлечены в понижающей из стержня наружного сегмента фагоцитоза с помощью ПЭС. Это явление частично объясняется сохранением фовеа при дегенерации желтого пятна .
Смотрите также
Рекомендации
Внешние ссылки
| Поищите меланин в Викисловаре, бесплатном словаре. |
Определяется ли цвет волос генетически ?: MedlinePlus Genetics
Цвет волос определяется количеством пигмента меланина в волосах. Изобилие одного типа меланина, называемого эумеланином, дает людям черные или каштановые волосы. Изобилие другого пигмента, называемого феомеланином, придает людям рыжие волосы.
Цвет волос | Тип и количество меланина |
|---|---|
Черный | Большое количество эумеланина |
Коричневый | Умеренное количество эумеланина |
Блондин | Очень мало эумеланина |
Красный | Преимущественно феомеланин с небольшим количеством эумеланина |
Тип и количество меланина в волосах определяется многими генами, хотя о большинстве из них мало что известно.Наиболее изученный ген окраски волос у людей называется MC1R . Этот ген предоставляет инструкции по созданию белка, называемого рецептором меланокортина 1, который участвует в пути, производящем меланин. Рецептор меланокортина 1 контролирует, какой тип меланина вырабатывается меланоцитами. Когда рецептор включается (активируется), он запускает серию химических реакций внутри меланоцитов, которые стимулируют эти клетки производить эумеланин. Если рецептор не активирован или заблокирован, меланоциты производят феомеланин вместо эумеланина.Многие другие гены также помогают регулировать этот процесс. У большинства людей есть две функционирующие копии гена MC1R , по одной унаследованной от каждого родителя. У этих людей черные или коричневые волосы из-за большого количества эумеланина. По оценкам, более 90 процентов людей в мире имеют каштановые или черные волосы.
У некоторых людей есть вариации в одной копии гена MC1R в каждой клетке, что вызывает отключение (деактивацию) гена. Этот тип генетического изменения описывается как потеря функции.У этих людей выработка эумеланина ниже, а выработка феомеланина выше, поэтому волосы у них клубнично-русые, каштановые или рыжие. У еще меньшего процента людей обе копии гена MC1R в каждой клетке имеют изменения, связанные с потерей функции, и путь производства меланина производит только пигмент феомеланин. Волосы у этих особей почти всегда очень красные. Даже когда путь производства меланина производит эумеланин, изменения в других генах могут снизить количество продуцируемого эумеланина.Эти изменения приводят к светлым волосам.
Цвет волос варьируется в широком спектре оттенков, от льняного блонда до угольно-черного. Многие гены, кроме MC1R, играют роль в определении оттенков цвета волос, контролируя уровни эумеланина и феомеланина. Некоторые из этих генов, включая ASIP , DTNBP1 , GPR143 , HPS3 , KITLG , MLPH , MYO5A , MYO7A , OCA2 , SLC5A , TYRP1 , TYR, ERCC6 , GNAS , HERC2 , IRF4 , OBSCN , SLC24A4 , TPCN2 и MITF , участвуют в производстве меланина в волосах. .Некоторые из этих генов связаны с транскрипцией генов (которая является первым шагом в производстве белка), репарацией ДНК, переносом веществ (таких как кальций) через клеточные мембраны или структурой волосяных фолликулов. Некоторые из этих генов влияют на цвет глаз и кожи, но точная роль, которую они играют в определении цвета волос, неизвестна.
Цвет волос со временем может измениться. В частности, у людей европейского происхождения светлые волосы могут потемнеть по мере взросления. Например, у светловолосых детей к подростковому возрасту волосы часто становятся темнее.Исследователи предполагают, что определенные белки пигмента волос активируются по мере взросления детей, возможно, в ответ на гормональные изменения, которые происходят в период около полового созревания. Почти у всех волосы начинают седеть с возрастом, хотя когда это происходит и в какой степени, варьируется. Седые волосы частично передаются по наследству и могут варьироваться в зависимости от этнического происхождения; это также в некоторой степени зависит от внешних факторов, таких как стресс. Волосы становятся седыми, когда волосяной фолликул теряет способность вырабатывать меланин, но точно неясно, почему это происходит.
Статьи в научных журналах для дальнейшего чтения
Браницки В., Лю Ф., ван Дуйн К., Драус-Барини Дж., Пошпех Э., Уолш С., Купец Т., Вояс-Пелц А., Кайзер М. Прогнозирование цвета волос человека на основе моделей с использованием вариантов ДНК. Hum Genet. 2011 Апрель; 129 (4): 443-54. DOI: 10.1007 / s00439-010-0939-8. Epub 2011, 4 января. PubMed: 21197618. Полный текст доступен бесплатно в центре PubMed: PMC3057002.
Commo S, Gaillard O, Thibaut S, Bernard BA. Отсутствие TRP-2 в меланогенных меланоцитах волос человека.Pigment Cell Res. 2004 Октябрь; 17 (5): 488-97. PubMed: 15357835.
Хан Дж., Крафт П., Нан Х, Го К., Чен С., Куреши А., Хэнкинсон С. Е., Ху Ф. Б., Даффи Д. Л., Чжао З. З., Мартин Н. Г., Монтгомери Г. В., Хейворд Н. К., Томас Дж., Гувер Р. Н., Чанок С., Хантер DJ. Полногеномное ассоциативное исследование выявляет новые аллели, связанные с цветом волос и пигментацией кожи. PLoS Genet. 2008 16 мая; 4 (5): e1000074. DOI: 10.1371 / journal.pgen.1000074. PubMed: 18483556. Полный текст доступен бесплатно в центре PubMed: PMC2367449.
Ито С, Вакамацу К.Разнообразие пигментации волос человека по данным химического анализа эумеланина и феомеланина. J Eur Acad Dermatol Venereol. 2011 декабрь; 25 (12): 1369-80. DOI: 10.1111 / j.1468-3083.2011.04278.x. PubMed: 22077870.
Лю Ф., Вэнь Б., Кайзер М. Цветные полиморфизмы ДНК у людей. Semin Cell Dev Biol. 2013 июнь-июль; 24 (6-7): 562-75. DOI: 10.1016 / j.semcdb.2013.03.013. Epub 2013, 12 апреля. PubMed: 23587773.
Schaffer JV, Болонья, JL. Рецептор меланокортина-1: рыжие волосы и не только. Arch Dermatol.2001 ноя; 137 (11): 1477-85. PubMed: 11708951.
Siewierska-Górska A, Sitek A, dzińska E, Bartosz G, Strapagiel D. Ассоциация пяти SNP с цветом человеческого волоса среди населения Польши. Homo. 2017 Март; 68 (2): 134-144. DOI: 10.1016 / j.jchb.2017.02.002. Epub 2017 4 февраля. PubMed: 28242083.
Штурм РА. Молекулярная генетика пигментационного разнообразия человека. Hum Mol Genet. 2009 15 апреля; 18 (R1): R9-17. DOI: 10,1093 / hmg / ddp003. PubMed: 19297406.
Тобин DJ. Пигментация человеческого волоса — биологические аспекты.Int J Cosmet Sci. 2008 Авг; 30 (4): 233-57. DOI: 10.1111 / j.1468-2494.2008.00456.x. PubMed: 18713071.
Что придает цвет волосам?
, Фейт Брини, доктор философии
Поместите один волосок под микроскоп, и вы увидите гранулы черного, коричневого, желтого или красного пигмента. Вы видите крошечные частицы меланина, того же пигмента, который придает цвет коже. Внутри волосяных фолликулов особые клетки, называемые меланоцитами, производят меланин, который откладывается в среднем слое, или коре, трехслойного стержня волоса.По мере роста волос вверх пигмент продолжает формироваться в клетках коры. Некоторые волосяные фолликулы производят больше пигмента, чем другие. Обычно волосы бровей — это волосы самого темного цвета на теле.
В волосах, как и в коже, есть два вида меланина. Эумеланин делает волосы черными или коричневыми. Феомеланин делает его красным или светлым. Только рыжие или те, у кого есть гены рыжих волос, производят феомеланин. Рыжие волосы являются результатом того, что феомеланин почти скрыт эумеланином, а феомеланин, присутствующий в небольших количествах, может сделать черные волосы блестящими.
Производство пигментов меняется с возрастом. Часто у белых блондинов в младенчестве волосы становятся темнее по мере взросления. Седые или белые волосы в старости являются результатом потери активности меланоцитов. У молодых людей фермент тирозиназа расщепляет аминокислоту тирозин, что является важным этапом в производстве меланина. По мере того, как люди становятся старше, вырабатывается меньше этого фермента, поэтому вырабатывается меньше меланина. В конце концов, стержень волоса вырастает практически без пигмента в коре головного мозга.Остался цветной кератин. Кератин — основной белок, формирующий структуру стержня волоса. Кератин без меланина выглядит желтовато-серым.
Об авторе
Фейт Брини, доктор философии
Фейт Брини имеет степень бакалавра искусств. Имеет степень бакалавра биологии Университета Западной Вирджинии и степень магистра и доктора наук по учебной программе и инструкциям Университета Колорадо. Она пишет книги и статьи на темы науки и здоровья для детей, подростков и взрослых, не являющихся учеными.Некоторые из ее книг получили награды, в том числе две цитаты «Лучшая книга года» Американской ассоциации развития науки.
Я спрашиваю себя: почему у меня светлые волосы и голубые глаза?
by Veronique Demers-Mathieu , Blogger
Вы можете посмотреть некоторые определения в конце, если что-то неясно 😉
Гены играют фундаментальную роль в определении цвета глаз, кожи и волос.Почему у вас повышенная чувствительность / устойчивость к солнечным ожогам? (Моя солнечная кожа против той кожи лобстера, которую унаследовал MC…)
Цвет кожи
Цвет кожи (пигментация) обусловлен количеством меланина, вырабатываемого меланосомами, которые отвечают за синтез, хранение и транспортировку меланина. Существует два типа меланина:
эумеланин, коричневый / черный пигмент
феомеланин , более светлый пигмент желтый / красный
Экологические и генетические изменения (потеря / увеличение генов или аллелей) влияют на производство и тип меланина.
Человек с темной кожей имеет богатую эумеланином пигментацию и аллели устойчивости к солнцу (локус MC1R), которые снова защищают от солнечных ожогов или покраснений (УФ-излучение или условия УФИ). Чем выше соотношение эумеланин / феомеланин, тем выше защита от УФИ.
Уровень эумеланина в коже можно повысить, употребляя в пищу продукты, богатые тирозином (меланин получают из тирозина) и витамином А, например молоко, яйца, сыры, рыбу, морковь, помидоры, красный перец и манго.Чтобы защитить кожу от солнечных ожогов и улучшить загар, вы можете включить в свой рацион витамин C (такие продукты, как апельсины, манго, киви и клубника) и витамин E (растительные масла, орехи и семечки). Витамин С играет важную роль в защите клеток кожи. MC, нашему главному редактору, определенно следует начать есть больше этих полезных продуктов, чтобы улучшить ее загар 😉
Человек со слегка пигментированной кожей (светлые / рыжие волосы) имеет более низкое соотношение эумеланин / феомеланин и более высокую чувствительность к солнечным ожогам, чем человек с темной кожей.
Соотношение эумеланин (коричневый / черный пигмент) / феомеланин (желтый / красный пигмент) определяет цвет кожи.Волосы
Как и кожа, окраска волос и глаз в основном определяется концентрацией меланина, вырабатываемого и хранящегося в меланосомах.
- Светлые волосы были связаны с мутацией гена TYRP1 (этот ген контролирует фермент, связанный с тирозиназой, белок1 (TYRP1), который играет роль в синтезе меланина) и гена KITLG (этот ген влияет на рост меланосом. ).Мутация этих генов вызывает снижение выработки меланина (Можете считать меня светловолосым мутантом;))
- Рыжие волосы были связаны с мутацией гена MC1R (рецептора меланокортина-1) (этот ген индуцирует низкую продукцию эумеланин-коричневого / черного пигмента и высокую продукцию феомеланина).
- Темные волосы содержат много генов, которые способствуют этому фенотипу, но конкретные гены до сих пор неизвестны.
Как минимум две пары генов контролируют цвет человеческого волоса:
- У человека со светлыми волосами (Vero) есть два рецессивных аллеля светлых волос «bb» (без коричневого аллеля).
- Человек с каштановыми волосами (MC и Jade) имеет либо доминантный коричневый аллель, либо рецессивный аллель светлого (Bb), либо два коричневых аллеля (BB). Поэтому у двух шатенок с двумя «Bb» может родиться белокурый ребенок (bb). Доминантный аллель (коричневый) маскирует рецессивный аллель (светлый или красный).
- У человека с рыжими волосами есть два аллеля рыжеволосого (rr).
Цвет глаз
Краткое определение формы глаз: «Ирис» — это цветная кольцеобразная мембрана за роговицей глаза с регулируемым круглым зрачком в центре.
Окраска радужной оболочки у современной популяции коричневая, варьируется от светлого до темного. Фенотип радужной оболочки глаза определяется (так же, как кожа и волосы) количеством меланина и соотношением эумеланина / феомеланина в радужной оболочке, у голубых глаз соотношение эумеланина / феомеланина ниже, чем у карих глаз.
Темная окраска радужной оболочки может быть более надежной защитой от солнца и высокого ультрафиолетового излучения, чем голубые глаза из-за высокого уровня эумеланина. Если у вас голубые глаза и светлые волосы, как у меня, вам следует быть осторожнее с экспозицией на солнце.🙂
Но какова вероятность получить цвет наших глаз?
Цвет глаз связан с доминантными и рецессивными генами, и поэтому цвет глаз может дать некоторые основные подсказки об отцовстве. Человек с одним доминантным и одним рецессивным аллелем гена будет иметь доминантный фенотип. Итак…
Коричневый преобладает над синим и зеленым (коричневый> синий или зеленый), а зеленый преобладает над синим (зеленый> синий). Синий всегда рецессивен!
Например:
- Человек с голубыми глазами (Веро) имеет два рецессивных аллеля синего глаза
(bb). - Человек с карими глазами (Gen & Anna) может иметь один доминантный аллель карих глаз и один рецессивный аллель голубого глаза (Bb) ИЛИ аллель карих глаз и аллель зеленого глаза (BG) ИЛИ два доминантных аллеля карих глаз (BB).
- Человек с зелеными глазами (MC) может иметь либо два аллеля зеленого глаза (GG), либо один аллель голубого глаза и один аллель зеленого глаза (Gb)
- Если я беременна (голубые глаза, bb), а у моего партнера голубые глаза (bb), то у моего ребенка будут голубые глаза с вероятностью 99%! (Если нет, мне нужно задать себе серьезные вопросы, хахаха)
- Опять же, если у моего партнера карие глаза (Bb), у моего ребенка все равно будет 50% шанс получить голубые глаза.Однако, если у него карие глаза (BB), у моего ребенка шанс иметь голубые глаза только 25%.
- Если у моего партнера зеленые глаза (Gb), у моего ребенка изменение на 50% на голубые глаза и на 50% на зеленые глаза.
Мы можем определить процент вероятности цвета глаз ребенка по цвету глаз родителей (см. Ниже).
ОПРЕДЕЛЕНИЯ 101:
Наука о красках волос
Цвет волос значительно влияет на наш внешний вид и нашу личность.Таким образом, продукты для окрашивания волос предлагают нам возможность иметь цвет волос по нашему выбору сегодня. Однако, естественно, мы рождаемся с определенным цветом волос, который может отличаться от цвета волос наших друзей, кузенов или даже членов нашей семьи. Фундаментальный фактор в нашем организме, определяющий цвет волос, определяется количеством пигмента меланина в волосах.
Источник
Эумеланин и феомеланин — два пигмента, которые играют важную роль в окрашивании волос. Интересно, что у всех в волосах есть пигмент феомеланин, который придает волосам оранжевый и красный цвет.Уровни черного или коричневого эумеланина определяют, насколько темными будут волосы и какой цвет будет преобладающим. Как и следовало ожидать, низкие концентрации пигмента эумеланина дают светлые волосы, а высокие концентрации приводят к более темным каштановым волосам. У людей с натуральными рыжими волосами уровень феомеланина в волосах намного выше, чем у людей с более распространенными цветами волос, такими как коричневый, светлый и черный. Чтобы было проще понять, вот диаграмма.
Базовые краски для волос — по типу и количеству пигментов меланина
Черный: Большое количество эумеланина
Коричневый: Умеренное количество эумеланина
Светлый: Очень мало эумеланина
Красный: Преимущественно феомеланин с небольшим количеством эумеланина
От чего зависит количество пигментов меланина в наших волосах?
Науку о нашем цвете можно объяснить немного физикой, а также биологией и химией.Хотя поглощение и отражение света также определяют цвет волос, основным фактором, определяющим наш основной цвет волос, являются наши гены. Как упоминалось выше, цвет и цвет волос придают тип и количество пигментов меланина в наших волосах. Общее количество меланина и соотношение между эумеланином и феомеланином уникально для нас и полностью определяется нашими генами. Это то, что придает естественный цвет волосам. Тем не менее, это не один или несколько из них; что интересно, в производстве меланина участвуют несколько генов, которые, следовательно, могут влиять на цвет наших волос.Эти гены включаются и выключаются в разные моменты нашей жизни — поэтому наши волосы меняют цвет с возрастом.
Генетика естественного цвета волос
MC1R — наиболее изученный ген цвета волос у людей. Меланины — это пигменты, полученные из аминокислоты тирозина. Цвет волос зависит от количества и типа меланина, вырабатываемого меланоцитами. Рецептор меланокортина 1 (MC1R) — это ген, ответственный за определение цвета волос. Они обнаруживаются на поверхности меланоцитов, а также в других клетках и играют роль в иммунной функции человека.Есть три типа натурального меланина.
Когда MC1R находится в активном состоянии, он производит эумеланин, вызывающий темные волосы. Также он отвечает за защиту кожи от повреждений ультрафиолетовым излучением.
Когда MC1R находится в неактивном состоянии, меланоциты вырабатывают феомеланин, который вызывает светлые или рыжие волосы. У этого пигмента отсутствует способность защищать кожу от солнечных лучей.
Поскольку он содержится в дофаминовых нейронах, он окрашивает некоторые области мозга, что не имеет прямого отношения к цвету волос.Мутация нейромеланина может привести к нейродегенеративному расстройству, которое имеет косвенное отношение к цвету волос.
Рецептор меланокортина 1 (MC1R)
Ген рецептора меланокортина 1 предоставляет инструкции по созданию белка, называемого рецептором меланокортина 1, который участвует в пути, производящем меланин. Поскольку рецептор меланокортина 1 контролирует, какой тип меланина вырабатывается меланоцитами. Когда рецептор включается (активируется), он запускает серию химических реакций внутри меланоцитов, которые стимулируют эти клетки производить эумеланин.Если рецептор не активирован или заблокирован, меланоциты производят феомеланин вместо эумеланина. Многие другие гены также помогают регулировать этот процесс. У большинства людей есть две функционирующие копии гена MC1R, по одной унаследованной от каждого родителя. У этих людей черные или коричневые волосы из-за большого количества эумеланина. По оценкам, более 90 процентов людей в мире имеют каштановые или черные волосы.
У некоторых людей есть вариации в одной копии гена MC1R в каждой клетке, что приводит к выключению (деактивации) гена.Этот тип генетического изменения описывается как потеря функции. У этих людей выработка эумеланина ниже, а выработка феомеланина выше, поэтому волосы у них клубнично-русые, каштановые или рыжие. У еще меньшего процента людей обе копии гена MC1R в каждой клетке имеют изменения, связанные с потерей функции, а путь производства меланина производит только пигмент феомеланин. Волосы у этих особей почти всегда очень красные. Даже когда путь производства меланина производит эумеланин, изменения в других генах могут снизить количество продуцируемого эумеланина.Эти изменения приводят к светлым волосам.
Цвет волос варьируется в широком спектре оттенков, от льняного блонда до угольно-черного. Многие гены, кроме MC1R, играют роль в определении оттенков цвета волос, контролируя уровни эумеланина и феомеланина. Некоторые из этих генов, включая ASIP, DTNBP1, GPR143, HPS3, KITLG, MLPH, MYO5A, MYO7A, OCA2, SLC45A2, SLC24A5, TYRP1, TYR, ERCC6, GNAS, HERC2, IRF4, OBSCN, TPCFN2, и участвует в производстве меланина в волосах. Некоторые из этих генов связаны с транскрипцией генов (которая является первым шагом в производстве белка), репарацией ДНК, переносом веществ (таких как кальций) через клеточные мембраны или структурой волосяных фолликулов.Некоторые из этих генов влияют на цвет глаз и кожи, но точная роль, которую они играют в определении цвета волос, неизвестна.
Цвет волос со временем может измениться. В частности, у людей европейского происхождения светлые волосы могут потемнеть по мере взросления. Например, у светловолосых детей к подростковому возрасту волосы часто становятся темнее. Исследователи предполагают, что определенные белки пигмента волос активируются по мере взросления детей, возможно, в ответ на гормональные изменения, которые происходят в период около полового созревания.Почти у всех волосы начинают седеть с возрастом, хотя когда это происходит и в какой степени, варьируется. Седые волосы частично передаются по наследству и могут варьироваться в зависимости от этнического происхождения; это также в некоторой степени зависит от внешних факторов, таких как стресс. Волосы становятся седыми, когда волосяной фолликул теряет способность вырабатывать меланин, но точно неясно, почему это происходит. (Источник)
Гены, отвечающие за пять основных цветов волос
Человеческие волосы преимущественно могут быть пяти разных цветов: черного, коричневого, светлого, белого / серого и, реже, красного.Среди этих основных цветов также существуют разные оттенки. За определенным цветом наших волос стоит интересная генетическая наука.
Белый / серый цвет волос
Белый / серый цвет волос в основном связан с недостатком (или низким количеством) одного из двух меланинов.
Черный цвет волос
Черный цвет волос обычно встречается в Азии и Африке из-за того, что люди в этих регионах, как правило, имеют более низкий уровень тирозиназы в организме. Секреция черного эумеланина заставляет волосы становиться черными, что указывает на то, что MC1R находится в активном состоянии.
Коричневый цвет волос
Человеческие волосы коричневого цвета имеют множество оттенков, таких как коричнево-черное дерево, коричнево-красное дерево, коричнево-дуб и т.д. конкретное пятно на хромосоме. Например, у людей с коричнево-черными волосами есть некоторые аллели, которые катализируют ферменты, чтобы произвести большое количество коричневого пигмента. Некоторые аллели у людей с коричнево-шведским блондом подавляют выработку ферментов, что, в свою очередь, снижает выработку коричневого пигмента.На основании этой аллель-ферментной активности оттенок коричневого цвета волос различается.
Светлый цвет волос
Светлые волосы образуются при наличии меньшего количества коричневого эумеланина при отсутствии других пигментов. Людей со светлыми волосами чаще всего можно увидеть в европейских странах. Полногеномные ассоциативные исследования (GWAS) показали, что мутантный ген, ответственный за белокурость в североевропейской популяции, — это лиганд KIT (KITLG), который обладает способностью бороться с раком кожи.Лиганд KIT отвечает за мутации цвета кожи, стволовых клеток крови и сперматозоидов. Гены, участвующие в производстве пигментов, содержат однонуклеотидные полиморфизмы (SNP) или нуклеотид аденингуанина, который изменяет количество KITLG, присутствующего в волосяном фолликуле. Мутация SNP или аденин-гуанинового нуклеотида была отмечена как потенциальный элемент фенотипа светлых волос.
Красный цвет волос
Рыжий цвет волос очень редок во всем мире. Они обитают в Северной Европе, особенно в Великобритании и Ирландии.Ген, присутствующий в рыжих волосах, рецессивен. Красный цвет вызван серией мутаций в гене MC1R, который передает волосам больше феомеланина; это также приводит к бледности кожи. Расположение аминокислот в белке у рыжеволосых людей отличается от такового у людей с волосами другого цвета. Рыжие очень страдают из-за повышенного риска солнечных ожогов и рака кожи, поскольку феомеланин не защищает кожу от солнечного света. Люди с генами рыжих волос более склонны к раку кожи.
В заключение
Ультрафиолетовое излучение солнечного света мгновенно запускает мутацию гена MC1R, а также увеличивает стадию мутации в опухоли. Ученые обнаружили, что люди с двумя аллелями MC1R чаще болеют меланомой, чем люди с одним вариантом гена MC1R. Вариант гена MC1R снижает синтез нейромедиаторов дофамина в головном мозге. Таким образом, рыжеволосым людям требуется большее количество анестетика, и они очень чувствительны к термической боли.
Также прочтите — Почему у людей разные цвета кожи?
Поделиться — это забота!
Меланин: типы и связанные с ним заболевания
Меланин — это естественный пигмент кожи. Цвет волос, кожи и глаз у людей и животных в основном зависит от типа и количества имеющегося у них меланина. Особые клетки кожи, называемые меланоцитами, производят меланин.
У всех одинаковое количество меланоцитов, но одни люди производят больше меланина, чем другие.Если эти клетки производят лишь немного меланина, ваши волосы, кожа и радужная оболочка глаз могут стать очень светлыми. Если ваши клетки производят больше, ваши волосы, кожа и глаза станут темнее.
Количество меланина, вырабатываемого вашим телом, зависит от ваших генов. Если у ваших родителей много или мало пигмента на коже, вы, вероятно, будете похожи на них.
Как меланин реагирует на солнце
Когда вы находитесь на солнце, ваше тело вырабатывает больше меланина. Это может помочь защитить организм от вредных ультрафиолетовых (УФ) лучей.
Но этого недостаточно, чтобы защитить вас от солнца. Ваша кожа уже повреждена, если вы обгорели на солнце или ваша кожа немного потемнела. Вот почему так важно всегда закрывать глаза и пользоваться солнцезащитным кремом.
Исследования показывают, что у людей с темной кожей меньше случаев рака кожи, чем у людей со светлой кожей. Необходимы дополнительные исследования, чтобы узнать, связано ли это с количеством меланина в их коже.
Типы меланина
Люди делятся на три типа:
- Эумеланин делает в основном темные цвета волос, глаз и кожи.Есть два типа эумеланина: коричневый и черный. Черные и коричневые волосы происходят из различных смесей черного и коричневого эумеланина. Светлые волосы возникают, когда есть небольшое количество коричневого эумеланина и нет черного эумеланина.
- Феомеланин окрашивает розоватые части вашего тела, такие как губы и соски. Рыжие волосы появляются при одинаковом количестве феомеланина и эумеланина. Клубнично-светлые волосы возникают, когда у вас есть коричневый эумеланин и феомеланин.
- Нейромеланин Управляет цветом нейронов.Это не связано с раскрашиванием вещей, которые вы видите.
Меланоциты вырабатывают эумеланин и феомеланин. Нейромеланин находится в головном мозге.
Нарушения, связанные с меланином
Проблемы с меланином связаны с несколькими нарушениями пигментации кожи.
Продолжение
Альбинизм . Это редкое заболевание возникает из-за очень малого количества меланина. У людей с альбинизмом белые волосы, голубые глаза и бледная кожа, а также могут быть проблемы со зрением. Им следует носить защиту от солнца, чтобы избежать повреждений от солнца.Нет лечения.
Продолжение
Melasma . У людей с меланодермией на лице появляются коричневатые пятна. Исследователи считают, что это вызвано гормонами, противозачаточными таблетками и воздействием солнца. Кремы по рецепту могут осветлить меланодермию, а солнцезащитные кремы могут предотвратить ее ухудшение. Также могут помочь лазерное лечение и химический пилинг.
Витилиго . Когда вы теряете меланоциты, на коже появляются гладкие белые пятна. Лекарства нет, но лечение включает в себя красители, терапию ультрафиолетовым светом, светочувствительные лекарства, кремы с кортикостероидами и хирургическое вмешательство.
Потеря пигмента после повреждения кожи . Иногда после того, как ваша кожа обожжена, покрыта волдырями или инфицирована, ваше тело не может заменить меланин в поврежденной области. Вам не понадобится лечение. Вы можете покрыть эту область косметикой, если она вас беспокоит.
Болезнь Паркинсона . При болезни Паркинсона нейромеланин в вашем мозгу падает, поскольку клетки мозга в области, называемой черной субстанцией, умирают. Обычно количество нейромеланина в мозге увеличивается с возрастом.
Потеря слуха . Меланин, кажется, играет роль в слухе. Ранние исследования показывают связь между недостатком меланина и потерей слуха или глухотой.
Количественное определение маркеров эумеланина и феомеланина в различных биологических образцах методом ВЭЖХ-УФ-МС после твердофазной экстракции
Abstract
Эумеланин и феомеланин — хорошо известные и распространенные пигменты, встречающиеся в природе. Однако их сложная полимерная структура и высокая термостабильность затрудняют их прямую химическую идентификацию.Широко используемым аналитическим методом является непрямое определение с помощью ВЭЖХ с УФ-детектированием обоих типов меланина по наиболее распространенным продуктам их окисления: пиррол-2,3-дикарбоновой кислоте (PDCA), пиррол-2,3,5-трикарбоновой кислоте (PTCA). , тиазол-4,5-дикарбоновая кислота (TDCA) и тиазол-2,4,5-трикарбоновая кислота (TTCA). Растущий интерес к пигментации в биологических исследованиях привел нас к разработке высокочувствительного и селективного метода для идентификации и количественного определения этих маркеров меланина в различных биологических образцах со сложными матрицами.Введя твердофазную экстракцию (SPE, обращенно-фазовую) после щелочного окисления, мы смогли значительно снизить фоновые сигналы, сохраняя при этом степень извлечения более 70%. Наш метод ВЭЖХ-УФ-МС позволяет уверенно идентифицировать пик с помощью точной информации о массе в соответствующих УФ-сигналах, используемых для количественного определения. Помимо синтетического меланина и чернил Sepia officinalis в качестве контрольных соединений маркеры эумеланина были обнаружены в коричневых человеческих волосах и коричневой раковине двустворчатых моллюсков ( Mytilus edulis ).Коричневые перья обычной курицы ( Gallus g . domesticus ) дали все четыре маркера эумеланина и феомеланина. Настоящий метод может быть легко адаптирован для широкого круга будущих исследований биологических образцов с неизвестным содержанием меланина.
Образец цитирования: Affenzeller S, Frauendorf H, Licha T., Jackson DJ, Wolkenstein K (2019) Количественное определение маркеров эумеланина и феомеланина в различных биологических образцах с помощью ВЭЖХ-УФ-МС после твердофазной экстракции.PLoS ONE 14 (10): e0223552. https://doi.org/10.1371/journal.pone.0223552
Редактор: Джозеф Бануб, Fisheries and Oceans Canada, CANADA
Поступило: 11 июля 2019 г .; Одобрена: 24 сентября 2019 г .; Опубликовано: 17 октября 2019 г.
Авторские права: © 2019 Affenzeller et al. Это статья в открытом доступе, распространяемая в соответствии с условиями лицензии Creative Commons Attribution License, которая разрешает неограниченное использование, распространение и воспроизведение на любом носителе при условии указания автора и источника.
Доступность данных: Все соответствующие данные находятся в рукописи.
Финансирование: Это исследование финансировалось Deutsche Forschungsgemeinschaft (DFG) (https://www.dfg.de), грант WO 1491 / 4-2 для KW и JA 2108 / 2-1 и JA 2108/6 -1 DJJ. Финансирующие организации не играли никакой роли в дизайне исследования, сборе и анализе данных, принятии решения о публикации или подготовке рукописи.
Конкурирующие интересы: Авторы заявили, что никаких конкурирующих интересов не существует.
Введение
В научной литературе термин «меланин» используется для обозначения любого количества черных, темно-коричневых, оранжевых и желтых пигментов, которые являются нерастворимыми и очень термостабильными [1–7]. Более точное определение меланина будет заключаться в том, что они построены путем ферментативной окислительной полимеризации субъединиц ДОФА (L-3,4-дигидроксифенилаланин) [4, 8–12]. Стабильность и размеры образующихся макромолекул усложняют их анализ стандартными аналитическими методами [10, 12, 13].Хорошо зарекомендовавший себя в медицинских исследованиях на людях метод определения наиболее распространенных типов меланина (эумеланин и феомеланин) использует продукты окислительного разложения меланина (рис.1): пиррол-2,3-дикарбоновую кислоту (PDCA), пиррол-2,3. , 5-трикарбоновая кислота (PTCA), тиазол-4,5-дикарбоновая кислота (TDCA) и тиазол-2,4,5-трикарбоновая кислота (TTCA) [6, 14–17].
Дальнейшие эксперименты, основанные на первоначально установленном методе перманганата калия в качестве окислителя [14–16], дали упрощенный и более воспроизводимый протокол окисления с использованием щелочного окисления пероксидом водорода [6, 18–20].Высокоэффективная жидкостная хроматография (ВЭЖХ) с УФ-детектированием и подвижной фазой, состоящей из метанол-фосфатного буфера (pH 2,1), была использована для разделения и детектирования этих специфических продуктов окисления меланина [6, 20]. Этот метод был в основном разработан для анализа человеческого меланина в медицинских целях, таких как образцы волос и кожи, где присутствие меланина неоспоримо, а интерес в основном заключается в количественном анализе. Но в последние годы биологов все больше интересуют пигменты и цветовые узоры, а также их присутствие в различных биологических условиях [21–27].Для этих биологических образцов с неизвестным содержанием пигмента необходим более конкретный метод. Кроме того, в биологических образцах, таких как волосы, перья и ракушки, анализу меланина сильно мешает присутствие сложных органических матриц, возникающих в результате окисления белков и других соединений H 2 O 2 . Следствием естественно высоких фоновых сигналов в этих биологических образцах является то, что надежная идентификация пиков может быть очень сложной (сравните хроматограммы в Ito et al.[20], Williams et al. [25]). Поэтому необходимо введение простого этапа подготовки образца, который сводит к минимуму фоновые сигналы. Yu et al. [28] использовали для этой цели метод экстракции жидкость-жидкость, но систематически не проверяли влияние этого этапа на установленные маркеры окисления меланина. Хотя Rioux et al. [29] исследовали влияние твердофазной экстракции (ТФЭ) с использованием слабых анионообменных колонок на продукты окисления меланина, но сосредоточили внимание исключительно на клетках меланомы в качестве биологического образца и воздержались от адаптации метода для совместимости с методами масс-спектрометрии (МС).
Чтобы преодолеть ограничение низкой селективности, обеспечиваемой УФ-детектированием, в последних методах фосфатный буфер в элюенте заменен на муравьиную кислоту, что позволяет детектировать МС. Для обнаружения эумеланиновых пигментов методом времени пролета (TOF) MS требовалось препаративное разделение аналитов перед анализом MS [23], тогда как более чувствительные методы HPLC-MS / MS для анализа маркеров эумеланина PDCA и PTCA в ткани двустворчатых моллюсков [28] и PTCA в образцах волос [30].Однако до настоящего времени не сообщалось ни о каком методе полного хроматографического разделения и чувствительного МС-детектирования маркеров эумеланина и феомеланина.
Целью настоящего исследования является создание надежного аналитического метода очистки образцов SPE и последующего обнаружения и количественного определения даже следовых количеств всех четырех распространенных маркеров эумеланина и феомеланина из различных биологических образцов.
Материалы и методы
Химия и реактивы
Вода (степень градиента для ВЭЖХ) была приобретена у J.Т. Бейкер (Девентер, Нидерланды). Этилацетат Pestinorm® Supra Trace был приобретен в VWR Chemicals (Лёвен, Бельгия). Метанол LiChrosolv® (повышенный для ЖХ-МС), карбонат калия (степень для анализа) и карбонат кальция (степень для анализа) были получены от Merck KGaA (Дармштадт, Германия). Сульфит натрия (чистота p.a., степень чистоты ACS) и раствор перекиси водорода (≥ 30%, степень чистоты для анализа следов) были получены от Sigma-Aldrich (Сент-Луис, США). Ротипуран® муравьиная кислота (≥98%, годовая, класс ACS), ротипуран® соляная кислота (37%, стр.a., ACS, класс ISO) и гидрохлорид Pufferan® TRIS (≥ 99%, содержание в год) были приобретены у Carl Roth GmbH + Co. KG (Карлсруэ, Германия). Протеиназа К была приобретена у Qiagen GmbH (Hilden, Германия).
Стандарты и образцы
Стандарты продуктов окисления меланина PDCA, PTCA, TDCA и TTCA (приготовленные в соответствии с ранее опубликованными протоколами [31]) были любезно предоставлены профессором Шосуке Ито при концентрации исходного раствора 100 мкг / мл. Синтетический меланин (полученный окислением тирозина перекисью водорода) и меланин из Sepia officinalis были получены от Sigma-Aldrich (St.Луис, США) и использовались для разработки методов как известные стандарты эумеланина.
Образец человеческого волоса был подарен одним из авторов (S.A.). Средние коричневые волосы вырезали на расстоянии примерно 10 см от кожи головы, а затем разрезали на кусочки по 5 мм. Коричневое куриное перо было получено от домашней курицы ( Gallus gallus domesticus ). Анализы проводились на дистальном конце коричневого пера. Раковина двустворчатого моллюска Mytilus edulis была коммерчески приобретена на продовольственном рынке.Образцы раковины брали с дистального края роста, который имел коричневые продольные полосы.
Подготовка проб и окисление меланина
Все биологические образцы очищали деионизированной водой в ультразвуковой ванне в течение 10 мин и давали высохнуть. Для синтетического меланина и чернил Sepia использовали 0,2 мг меланина, для образцов пера и волос — 5,5 мг и для образца скорлупы — 1,5 г, соответственно. Окисление меланина проводили, как ранее опубликовано [20, 25], с некоторыми изменениями: приготовленные кусочки оболочки растворяли в HCl (6 M, приблизительно 7 мл) и центрифугировали при 13000 об / мин в течение 15 мин.Полученный супернатант отбрасывали, а остаток дважды промывали H 2 O.
Биологические образцы (волосы, перья и панцирь) обрабатывали 10 мкл протеиназы K (10 мг / мл) в 500 мкл буфера TRIS-HCl (1 M, pH 8,0) в течение 30 мин при 37 ° C на шейкере. Лечение прекращали добавлением 300 мкл HCl (6 М). Образцы центрифугировали при 13000 об / мин в течение 15 минут, супернатант удаляли, а осадок промывали водой.
Все реакции окисления (синтетический меланин, Sepia, чернил меланин, перо, волосы и скорлупа) проводили в течение 20 часов при 25 ° C с энергичным встряхиванием с использованием 100 мкл H 2 O, 375 мкл K 2 CO 3 (1 M) и 25 мкл H 2 O 2 (30%) в качестве реагентов.По истечении этого времени любой оставшийся H 2 O 2 был инактивирован добавлением 50 мкл Na 2 SO 3 (10% (мас. / Об.) И 140 мкл HCl (6 M). Затем образцы центрифугировали). при 13000 об / мин в течение 30 минут и супернатант переносили в свежую пробирку. В качестве отрицательного контроля обрабатывали 2,0 г карбоната кальция, как образец скорлупы. Для сравнения использовали смесь PTCA, PDCA, TTCA и TDCA в H 2 О (2,5 мкг / мл каждого) анализировали в тех же условиях, что и окисленные образцы.
Обработка образцов с использованием SPE
Окисленные образцы обрабатывали SPE на полимерных картриджах с обращенной фазой Strata ™ -X 33 мкм, 200 мг / 6 мл (Phenomenex, Torrance, USA) под вакуумом. Картриджи кондиционировали 5 мл метанола, а затем 5 мл H 2 O. Образцы загружали в картриджи для SPE, разбавленные 5 мл муравьиной кислоты (0,3% (об. / Об.)) И промывали один раз 5 мл муравьиной кислоты (0,3% (об / об)). Затем картриджи сушили в течение 30 мин и элюировали 3 мл метанола, а затем 3 мл этилацетата.Растворители удаляли в постоянном потоке азота при 40 ° C, и образцы повторно растворяли в 200 мкл H 2 O.
Хроматографическое разделение с УФ- и МС-детектированием
Измерения проводили на системе ВЭЖХ-МС Thermo Fisher Scientific, состоящей из ВЭЖХ Accela с детектором Finnigan Surveyor PDA и соединенной с масс-спектрометром LTQ Orbitrap XL, оборудованным источником ионизации электрораспылением (ESI). Хроматографическое разделение проводили на колонке Gemini C18 (размер частиц 5 мкм, 250 × 2 мм i.d. (Phenomenex, Торранс, США)). Аликвоты (10 мкл) образцов вводили в систему ВЭЖХ, работающую при скорости потока 0,2 мл / мин. Подвижная фаза состояла из 0,3% муравьиной кислоты (элюент A) и метанола (элюент B) (80:20), прогоняли изократически при 45 ° C в течение 20 минут с последующей стадией промывки A: B (5:95) для 10 мин и фаза уравновешивания для достижения начальных условий в течение 10 мин. УФ-данные были записаны в диапазоне от 200 до 400 нм. Количественное определение проводилось в диапазоне 250–290 нм. Масс-спектры снимали в режиме отрицательных ионов.Окно сканирования было установлено на м / z = 120–220. Оптимизированные условия МС включали: расход газа 50 (условные единицы), напряжение распыления 5,0 кВ и температуру нагретого капилляра 275 ° C.
Калибровка и проверка
Линейный диапазон метода был протестирован для каждого из продуктов окисления меланина с помощью калибровочной кривой из 9 точек при концентрациях от 0,01 до 10 мкг / мл путем многократных инъекций. Предел обнаружения (LOD) и предел количественного определения (LOQ) были определены методом отношения сигнал / шум для каждого из стандартов на основе измерений ВЭЖХ с УФ-детектированием.LOD был установлен на 3: 1, а LOQ на 10: 1 отношение сигнал / шум, соответственно.
Извлечение после пробоподготовки с помощью SPE было протестировано со смесью всех четырех продуктов окисления меланина в элюенте A. Кроме того, полное извлечение методом было исследовано для всех трех природных матриц (перо, волосы, скорлупа) с помощью трехточечного стандартного добавления (2 раз, 5 раз и 10 раз) всех продуктов окисления. Стандарты были добавлены после окисления матриц и до SPE. Извлечение SPE без матриц измеряли на системе ВЭЖХ Agilent серии 1200 с диодно-матричным детектором с использованием тех же хроматографических условий, которые описаны выше.
Дополнительные эксперименты по самому протоколу окисления подтвердили линейность образования PDCA и PTCA из синтетического стандарта эумеланина в диапазоне 0,05–0,4 мг. Тест с увеличенным временем окисления (40 ч) не привел к значительно большему количеству продуктов окисления и даже дал немного меньше маркеров эумеланина в случае образцов скорлупы.
Результаты и обсуждение
Разработка метода
Наш метод щелочного окисления меланина из широкого диапазона биологических образцов объединяет и уточняет множество ранее опубликованных протоколов [20, 21, 23, 25].Мы демонстрируем, что, включив этап очистки образца с помощью SPE и адаптировав хроматографическую систему для возможности двойного обнаружения с помощью УФ и МС, два маркера для эумеланина (PDCA и PTCA) и феомеланина (TDCA и TTCA) могут быть проанализированы в одном ВЭЖХ запуск. Мы смогли добиться разделения всех четырех маркеров окисления меланина по базовой линии для хроматографических условий, совместимых с масс-спектрометрией. Путем обессоливания и очистки образцов с помощью SPE мы могли значительно снизить фон различных исследованных нами образцов.Кроме того, стадия выпаривания дает преимущество концентрирования аналитов. Неожиданным наблюдением во время оптимизации обращенно-фазовой ВЭЖХ было то, что на время удерживания аналитов практически не влияла концентрация органического растворителя (от 15 до 25% метанола в элюенте). Поэтому мы использовали изократическое элюирование вместо градиентного. Напротив, время удерживания сильно зависело от значения pH элюента, эффект также наблюдался в недавнем исследовании [29].
Масс-спектры ESI высокого разрешения PDCA, TDCA и PTCA показывают ионные сигналы для депротонированных молекул [M – H] — .TDCA и PTCA показывают дополнительные ионы, возникающие в результате фрагментации CO 2 от одной из карбоксильных групп. Напротив, для TTCA можно наблюдать только фрагментные ионы, возникающие в результате потери одной и двух карбоксильных групп, что дает практически тот же масс-спектр, что и TDCA (см. Таблицу 1 и Фиг.2). Следовательно, идентификация и количественное определение как TDCA, так и TTCA возможно только путем включения хроматографического разделения. Все четыре продукта окисления меланина могут быть охарактеризованы их специфическими УФ-спектрами поглощения (рис. 2), когда нет мешающих фоновых пиков.Для количественного определения в МС требуются соответствующие внутренние стандарты, которых нет в продаже для анализируемых маркеров меланина. Напротив, количественный анализ с УФ-детектированием может быть выполнен со стандартами продуктов окисления меланина с помощью внешней калибровки или добавления стандарта. Однако идентификация пиков должна проводиться очень осторожно из-за естественного высокого фона, присутствующего в биологических образцах даже после очистки с помощью SPE (сравните Рис. 3). Благодаря сочетанию УФ-излучения с МС-детектированием с высоким разрешением прямой количественный анализ на основе УФ-сигналов может быть объединен с надежной идентификацией соединений в сложных биологических образцах.Кроме того, масс-спектрометрические измерения дают примерно в 1,5 раза более высокую чувствительность, чем УФ-обнаружение, что является важным фактором при анализе биологических образцов с неизвестным содержанием меланина.
Рис. 3. Сравнение хроматограмм экстрагированных ионов.
( a ) и соответствующая УФ-хроматограмма ( b ) продуктов окисления коричневого куриного пера после SPE, подчеркивая необходимость подтверждения пика в биологических образцах.
https: // doi.org / 10.1371 / journal.pone.0223552.g003
Предыдущие валидации методов анализа продуктов окисления меланина тщательно не проводились [6, 17, 20, 32]. Мы представляем здесь данные калибровки и валидации для количественного определения всех четырех стандартов продуктов окисления меланина с помощью УФ-детекции (таблица 2) после SPE. Линейность может быть продемонстрирована для обоих маркеров окисления эумеланина (PDCA и PTCA) в диапазоне 0,05–10 мкг / мл. Для маркеров окисления феомеланина (TDCA и TTCA) линейность колебалась от 0.1–10 мкг / мл.
Недавно опубликованное исследование ВЭЖХ-МС / МС на человеческих волосах определило LOD и LOQ для одного из четырех стандартных маркеров окисления меланина (PTCA) [30]. Наш метод позволяет обнаруживать все четыре продукта окисления в концентрациях 0,1 мкг / мл или меньше, для PTCA ниже или на уровне, сопоставимом с LOD, опубликованными ранее [21, 29, 30]. Оба маркера эумеланина могут быть определены количественно при концентрациях всего 0,1 мкг / мл. Для маркеров феомеланина самые низкие количественные концентрации составляли 0.25 мкг / мл для TDCA и 0,33 мкг / мл для TTCA.
Извлечение продуктов окисления меланина в элюенте A после SPE варьировалось от 67% для TTCA до 95% для TDCA (таблица 3). Сравнение количественного определения с помощью внешней калибровки и добавления стандарта во всех трех протестированных биологических матрицах дало хорошие результаты с извлечением более 70% маркеров эумеланина PDCA и PTCA. Маркеры феомеланина TDCA и TTCA демонстрируют широкий диапазон восстановления из различных матриц. Это можно объяснить взаимодействием различных матриц с условиями SPE, а также чистотой пиков.Эти наблюдения подчеркивают, что точное и точное количественное определение маркеров феомеланина в биологических матрицах должно проводиться очень тщательно с соответствующими контролями и повторами, и любые результаты следует интерпретировать критически.
Применение метода к сложным биологическим образцам
Оба маркера эумеланина PDCA и PTCA были обнаружены в синтетическом меланине и в меланине чернил Sepia officinalis (рис. 4). В синтетическом меланине оба продукта окисления эумеланина можно найти в аналогичных количествах (PDCA: 55.6% и PTCA 44,4% от общего количества маркеров меланина), тогда как в S . officinalis ink PTCA является преобладающим маркером (94,8% от общего количества маркеров меланина), только с небольшими количествами PDCA (5,2% от общего количества маркеров меланина) (Таблица 4). Этот эффект различий в соотношении выходов продуктов окисления приводит к предположению о разном составе исходных макромолекул [14, 20, 31]. Каждый биологический образец, исследованный в этом исследовании, давал различное соотношение PTCA / PDCA (Таблица 4). Для понимания этих различий и их влияния на цвет и функциональность потребуются дальнейшие исследования процесса полимеризации природных меланинов и исследования их химической структуры.Как и ожидалось, продукты окисления феомеланина TDCA и TTCA не могли быть обнаружены ни в одном из эталонных соединений меланина, измеренных здесь.
Рис. 4. Извлеченные ионные хроматограммы стандартов продуктов окисления меланина и эталонных соединений меланина (стандартная смесь продуктов окисления, синтетический эумеланин, чернила Sepia меланин), а также биологических образцов (человеческий волос, куриное перо, скорлупа двустворчатых моллюсков) после щелочного окисления .
https: // doi.org / 10.1371 / journal.pone.0223552.g004
Во всех трех исследованных биологических матрицах (перо, волосы, раковина) мы смогли обнаружить эумеланин (рис. 4 и табл. 4). В образцах пера и волос мы также могли обнаружить феомеланин. Уже было показано, что перья североамериканских ласточек ( Hirundo rustica erythrogaster ) содержат как эумеланины, так и феомеланины [21]. В том же исследовании изучали желтое куриное оперение птенцов и обнаружили следы эумеланина.Применив наш метод к коричневым перьям взрослых цыплят, мы обнаружили обилие всех четырех продуктов окисления, что подтверждает результаты предыдущих исследований электронного спинового резонанса [33].
Сложная биологическая матрица, из которой можно извлечь органические макромолекулы, — это кальцинированные раковины моллюсков. Слой, несущий пигмент, у Mytilus edulis очень тонкий, обеспечивая лишь небольшое количество пигмента из относительно большого количества материала оболочки. Тем не менее, нам удалось обнаружить эумеланин у этого двустворчатого моллюска, что является дополнительным доказательством того, что наш метод достаточно чувствителен для обнаружения этих пигментов в ряде биологических матриц.Пигментация и использование меланина для создания рисунка на раковинах и перламутровом материале различных моллюсков стали объектом исследований в последние годы [28, 34, 35]. Наш метод облегчает работу с этими сложными образцами и, мы надеемся, приведет к дальнейшим исследованиям пигментации раковин меланических моллюсков.
Особенно сложный тип образца состоит из окаменелых тканей и матриц, содержащих меланин. Хотя меланин кажется очень хорошо окаменелым [23, 36, 37], лишь немногие исследователи имеют доступ к достаточно материалам для анализа этих образцов с помощью хроматографических методов с УФ-детектированием.Масс-спектрометрические измерения ранее были выполнены для окаменелых чернил Sepia [23], которые обнаружили доказательства наличия эумеланина. Представленные здесь протоколы являются хорошей отправной точкой для дальнейших корректировок подготовки проб с помощью SPE и разработки еще более чувствительных методов МС для образцов ископаемых, предположительно содержащих меланин. Предварительные измерения с использованием детектирования МС / МС показали, что чувствительность нашего метода может быть улучшена на несколько порядков.
Заключение
Метод, который мы представляем здесь, позволяет исследователям обнаруживать эумеланин и феомеланин в различных сложных биологических образцах. Эффект очистки и концентрирования, обеспечиваемый SPE, и добавление масс-спектрометрии позволяет селективно идентифицировать даже небольшие количества (0,1 мкг / мл или меньше) известных продуктов окисления меланина. Масс-спектрометрия высокого разрешения позволяет уверенно идентифицировать пики даже в сложных биологических образцах с мешающим фоном и перекрывающимися пиками на хроматограммах, полученных с помощью УФ-детекции.
В отличие от сложного анализа исходных макромолекул, продукты окисления эумеланина и феомеланина могут быть определены количественно с помощью настоящего метода. Однако из-за различий в составе природных меланинов (например, различий в соотношении PDCA / PTCA в контрольных соединениях и биологических образцах) и матричных эффектов биологических образцов на SPE (см. Таблицу 3) мы рекомендуем использовать оба маркера окисления для каждого типа меланин как индикаторы содержания пигментов эумеланина и феомеланина в исходном образце.
Высокочувствительный метод, о котором мы сообщаем здесь, улучшает нашу способность одновременно обнаруживать эумеланин и феомеланин в различных сложных биологических образцах.
Благодарности
Авторы очень благодарны профессорам Шосуке Ито и Казумасе Вакамацу (кафедра химии, Школа медицинских наук Университета здоровья Фудзита) за предоставление стандартных растворов для продуктов окисления меланина. Мы благодарим Габриэле Мюллер за подаренное коричневое куриное перо.
Список литературы
- 1. Комфорт А. Пигментация раковин моллюсков. Biol Rev.1951; 26 (3): 285–301.
- 2. Свон Г. А., Вагготт А. Исследования, связанные с химией меланинов. Часть X. Количественная оценка различных типов единиц, присутствующих в допа-меланине. J. Chem Soc C 1970; (10): 1409–1418.
- 3. Свон Г. Структура, химия и биосинтез меланинов. Fortschr Chem Org Naturst. Спрингер, Вена; 1974. стр.521–582. pmid: 4372136
- 4. Райли PA. Меланин. Int J Biochem Cell Biol. 1997. 29 (11): 1235–1239. pmid: 9451820
- 5. Прота Г. Прогресс в химии меланинов и родственных метаболитов. Med Res Rev.1988; 8 (4): 525–556. pmid: 3057299
- 6. Вакамацу К., Ито С. Передовые химические методы определения меланина. Pigment Cell Res. 2002. 15 (3): 174–183. pmid: 12028581
- 7. Ито С., Вакамацу К. Количественный анализ эумеланина и феомеланина у людей, мышей и других животных: сравнительный обзор.Pigment Cell Res. 2003. 16 (5): 523–531. pmid: 12950732
- 8. Лернер А.Б., Фитцпатрик ТБ. Биохимия образования меланина. Physiol Rev.1950; 30 (1): 91–126. pmid: 15403662
- 9. Биннс Ф., Кинг Дж. А., Мишра С. Н., Персиваль А., Робсон Н. С., Свон Г. А. и др. Исследования, связанные с химией меланинов. Часть XIII. Исследования структуры дофамин-меланина. J. Chem Soc C. 1970 (15): 2063–2070.
- 10. Ито С. Пересмотр структуры эумеланина.Biochim Biophys Acta Gen Subj. 1986. 883 (1): 155–161.
- 11. д’Искья М., Наполитано А., Прота Г. Пероксидаза как альтернатива тирозиназе в окислительной полимеризации 5,6-дигидроксииндолов до меланина (ов). Biochim Biophys Acta Gen Subj. 1991; 1073 (2): 423–430.
- 12. Прота Г. Меланины и меланогенез. Нью-Йорк: Academic Press; 1992. С. 1-290.
- 13. Прота Г. Химия меланинов и меланогенез. Fortschr Chem Org Naturst.Спрингер, Вена; 1995. С. 93–148. pmid: 7782013
- 14. Пиаттелли М, Николаус РА. Структура меланинов и меланогенез — I: Структура меланина в Sepia. Тетраэдр. 1961. 15 (1–4): 66–75.
- 15. Николаус Р.А., Пиаттелли М., Фатторуссо Э. Структура меланинов и меланогенез — IV: О некоторых природных меланинах. Тетраэдр. 1964. 20 (5): 1163–1172. pmid: 5879158
- 16. Ито С., Фуджита К. Микроанализ эумеланина и феомеланина в волосах и меланомах путем химической деградации и жидкостной хроматографии.Анальная биохимия. 1985. 144 (2): 527–536. pmid: 3993914
- 17. Наполитано А., Пеццелла А., Винченси М.Р., Прота Г. Окислительное разложение эумеланинов до пиррольных кислот: модельное исследование. Тетраэдр 1995; 51: 5913–5920.
- 18. Ито С., Вакамацу К. Химическая деградация меланинов: применение для идентификации дофамина меланина. Pigment Cell Res. 1998. 11 (2): 120–126. pmid: 9585251
- 19. Вакамацу К., Фудзикава К., Зукка Ф.А., Зекка Л., Ито С. Структура нейромеланина, изученная методами химического разложения.J Neurochem. 2003. 86 (4): 1015–1023. pmid: 12887698
- 20. Ито С., Наканиши Ю., Валенсуэла Р.К., Бриллиант М.Х., Кольбе Л., Вакамацу К. Полезность щелочного окисления перекиси водорода для анализа эумеланина и феомеланина в различных образцах тканей: применение для химического анализа меланинов волос человека. Pigment Cell Melanoma Res. 2011. 24 (4): 605–613. pmid: 21535429
- 21. МакГроу К.Дж., Вакамацу К., Ито С., Нолан П.М., Джувентин П., Добсон Ф.С. и др. Вы не можете судить о пигменте по цвету: содержание каротиноидов и меланина в желтых и коричневых перьях ласточек, синих птиц, пингвинов и домашних цыплят.Кондор. 2004. 106 (2): 390–395.
- 22. Chen SR, Jiang B, Zheng JX, Xu GY, Li JY, Yang N. Выделение и характеристика природного меланина, полученного из шелковистой птицы ( Gallus gallus domesticus, Brisson). Food Chem. 2008. 111 (3): 745–749.
- 23. Гласс К., Ито С., Уилби П.Р., Сота Т, Накамура А., Бауэрс С.Р. и др. Прямые химические доказательства пигмента эумеланина юрского периода. Proc Natl Acad Sci U S. A. 2012; 109 (26): 10218–10223. pmid: 22615359
- 24.Кронфорст М.Р., Барш Г.С., Копп А., Маллет Дж., Монтейро А., Маллен С.П. и др. Распутывая нить гобелена природы: генетика разнообразия и конвергенции пигментации животных. Pigment Cell Melanoma Res. 2012. 25 (4): 411–433. pmid: 22578174
- 25. Уильямс С.Т., Ито С., Вакамацу К., Горал Т., Эдвардс Н.П., Вогелиус Р.А. и др. Определение пигментов окраски раковины морских улиток Clanculus pharaonius и C . margaritarius (Trochoidea; Gastropoda).PloS One. 2016; 11 (7): e0156664. pmid: 27367426
- 26. Катхилл И.К., Аллен В.Л., Арбакл К., Касперс Б., Чаплин Г., Хаубер М.Э. и др. Биология цвета. Наука. 2017; 357 (6350): eaan0221. pmid: 28774901
- 27. Williams ST. Цвет раковины моллюска. Биол Ред. 2017; 92 (2): 1039–1058. pmid: 27005683
- 28. Ю Ф, Пан З., Цюй Б, Ю Х, Сюй К., Дэн Й и др. Идентификация гена тирозиназы и его функциональный анализ в синтезе меланина Pteria penguin .Ген. 2018; 656: 1–8. pmid: 29496552
- 29. Rioux B, Rouanet J, Akil H, Besse S, Debiton E, Bouchon B и др. Определение эумеланина и феомеланина в меланомах с использованием твердофазной экстракции и анализа методом высокоэффективной жидкостной хроматографии с диодной матрицей (HPLC-DAD). J Chromatogr B. 2019; 1113: 60–68
- 30. Petzel-Witt S, Meier SI, Schubert Zsilavecz M, Toennes SW. PTCA (1H пиррол 2,3,5 трикарбоновая кислота) в качестве маркера окислительного лечения волос.Анальный тест на наркотики. 2018; 10 (4): 768–773. pmid: 28940782
- 31. д’Искья М., Вакамацу К., Наполитано А., Бриганти С., Гарсия-Боррон Дж. К., Ковач Д. и др. Меланины и меланогенез: методы, стандарты, протоколы. Исследование пигментных клеток и меланомы. 2013. 26 (5): 616–633.
- 32. Magarelli M, Passamonti P, Renieri C. Очистка, характеристика и анализ меланина сепии из коммерческих чернил сепии ( Sepia officinalis ) –– Purificación, caracterización y análisis de la melanina de sepia a partir de la tinta de sepia ( Sepia ).CES Medicina Veterinaria y Zootecnia. 2010. 5 (2): 18–28.
- 33. Сили Р.С., Хайд Дж.С., Феликс С.К., Менон И.А., Прота Г. Эумеланины и феомеланины: характеристика электронно-спиновой резонансной спектроскопией. Наука. 1982, 217 (4559): 545–547. pmid: 6283638
- 34. Hao S, Hou X, Wei L, Li J, Li Z, Wang X. Извлечение и идентификация пигмента в рубце приводящей мышцы тихоокеанской устрицы Crassostrea gigas . PloS One. 2015; 10 (11): e0142439. pmid: 26555720
- 35.Sun X, Wu B, Zhou L, Liu Z, Dong Y, Yang A. Выделение и характеристика пигмента меланина из гребешка yesso Patinopecten yessoensis . J Ocean Univ China. 2017; 16 (2): 279–284.
- 36. Коллеги С., Долокан А., Гарднер Дж., Сингх С., Вуттке М., Рабенштейн Р. и др. Химические, экспериментальные и морфологические доказательства диагенетически измененного меланина в исключительно сохранившихся окаменелостях. Proc Natl Acad Sci U S. A. 2015; 112 (41): 12592–12597. pmid: 26417094
- 37.Линдгрен Дж., Шевалл П., Тиль В., Чжэн В., Ито С., Вакамацу К. и др. Доказательства гомеотермии и крипсиса на основе мягких тканей у ихтиозавра юрского периода. Природа. 2018; 564 (7736): 359–365. pmid: 30518862
КАК ОБРАЗУЕТСЯ НАТУРАЛЬНЫЙ ЦВЕТ ВОЛОС
Волосы у корня живые, и к ним нужно обращаться осторожно и уважительно; при использовании химикатов для изменения цветовых свойств волос важно знать, как и почему происходят эти изменения.
Чем больше вы осведомлены, тем больше клиент будет вам доверять и прислушиваться к вашим советам.
Натуральные пигменты в волосах Меланин
Натуральный краситель для волос производится из крошечных гранул пигмента — меланина, который находится в фиброзном корковом слое волоса. Свет проникает через прозрачные чешуйки кутикулы, некоторые из которых отражаются обратно в глаз. Воспринимаемый нами цвет зависит от того, какой свет отражается обратно; Тип, количество и смесь двух пигментов, содержащихся в натуральных волосах, определяют это.
Тип клеток, называемый меланоцитами, отвечает за производство меланина в корневой луковице волоса.Катализатор тирозин, обнаруженный в меланоцитарных клетках, отвечает за запуск химической реакции, приводящей к образованию меланина. Здесь создаются два разных меланина: эумеланин от коричневого до черного и феомеланин от желтого до красноватого.
Комбинация эумеланина и феомеланина создает в волосах естественный цвет , а концентрация определяет глубину цвета.
Глубина и тон
Описание глубины цвета и тона может помочь определить и описать различные типы цвета.На глубину цвета влияет количество меланинов, содержащихся в волосах: большее количество меланинов делает волосы более темными, а меньшее количество пигментов делает волосы более светлыми.
Пигмент эумеланин является более доминирующим из двух из-за его коричневого или черного цвета. Глубину цвета можно разделить на десять уровней, от черного до светло-русого, однако в каждой глубине цвета есть несколько оттенков или тонов. Это относится к цветовому кругу , например, светлый блондин может иметь золотистый, матовый или серый (пепельный) оттенок.
Феомеланин в основном отвечает за основной тон волос. Когда цвет становится светлее, становятся очевидными определенные естественные тона, называемые полутонами.

